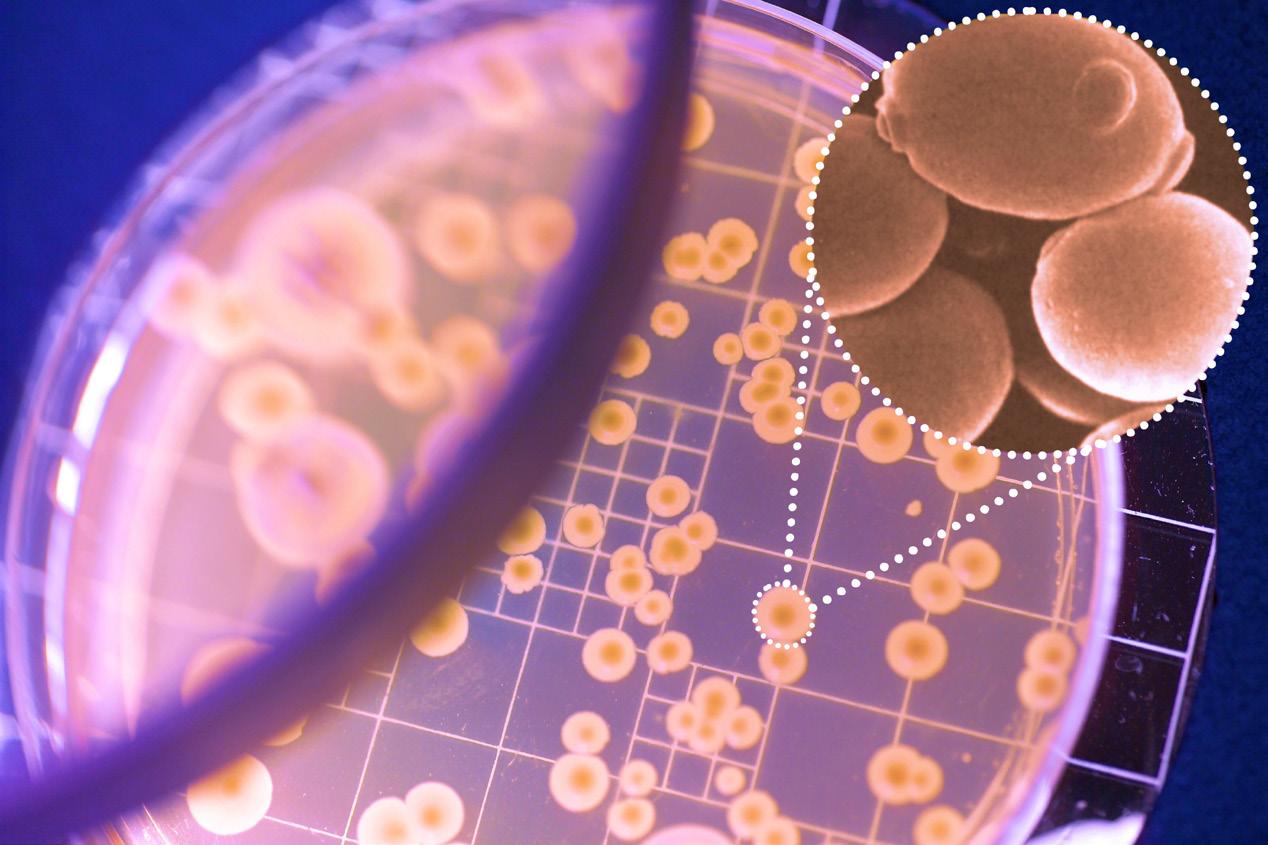

Anuário de Sustentabilidade do sistema bioenergético
e Guia de Compras das empresas fornecedoras











































































































BIOENERGIA + AÇÚCAR
BIOENERGIA + AÇÚCAR

BIOENERGIA + AÇÚCAR







se preparar

preparar para os possíveis eventos climáticos severos















![]()



Anuário de Sustentabilidade do sistema bioenergético
e Guia de Compras das empresas fornecedoras











































































































BIOENERGIA + AÇÚCAR
BIOENERGIA + AÇÚCAR

BIOENERGIA + AÇÚCAR







se preparar

preparar para os possíveis eventos climáticos severos















Somos uma empresa nordestina com sotaque mineiro; fizemos o caminho inverso ao do Rio São Francisco, que nasce em terras mineiras e desagua em solo alagoano. Nós da Usina Coruripe nascemos em Alagoas e crescemos e nos desenvolvemos em Minas Gerais. Temos, portanto, o DNA nordestino com características mineiras.
E, como todo bom nordestino, desde sempre convivemos com as variações climáticas, com muito sol e calor em uns períodos e outros com chuvas mesmo que de forma limitada, porém previstas. Existe uma máxima no Nordeste que nunca devemos reclamar do clima, ainda mais se for chuvoso. Em terras mineiras, viemos certos de encontrar um clima mais definido e estável, onde cada estação seria bem determinada, com períodos de chuvas regulares alternando com períodos de estiagem. Nas duas regiões, temperaturas variando dentro da normalidade.
Lidar com o clima sempre foi o grande desafio da agricultura. Essa realidade em que tínhamos estações definidas e claras não é mais a verdade. No Nordeste, chuvas mais acentuadas e concentradas, porém com variações irregulares a cada safra; no Sudeste, secas devastadoras e duradoras com períodos chuvosos incertos e totalmente desproporcionais. Nas duas regiões, hoje a grande certeza é que, a cada safra aumenta, o desafio pois não podemos mais trabalhar com dados históricos, uma vez que não existe mais uma previsão com tanta credibilidade como tínhamos no passado.
Estamos falando de mudanças climáticas e eventos extremos, em que as estações chuvosas variam a cada ciclo com uma instabilidade tamanha que fica quase impossível fazer um planejamento adequado e preciso. E com isso vem o grande desafio: como se planejar e se preparar.
A boa notícia é que já temos tecnologia para enfrentar esta nova era, mas requer grandes investimentos e principalmente disciplina. Nesta nova realidade, o planejamento passa por mudar a forma de observar a natureza e de interagir com ela.
No Nordeste, aprendemos cedo e investimos em preservação de água (temos um grande reservatório privado de água doce), que garante água em constância e ainda equilibra e controla a vazão do Rio Coruripe. E para abastecer e garantir o fluxo hídrico nessa represa, recuperamos as áreas de preservação permanente e aumentamos a preservação em áreas nativas para retenção e absorção de chuvas, além de realizarmos e praticarmos a agricultura regenerativa, onde o manejo adequado do solo com técnicas conservacionistas ajuda na retenção e absorção de água.
O caminho para o Centro-Sul deverá ser o mesmo: investimentos significativos em reserva de água através de barragens, tendo como objetivo mais importante reter o máximo possível de chuvas que se precipitam irregularmente. Projetos de irrigação robustos e de preferência direcionados para diminuir o consumo, priorizando irrigação em gotejamento com menor consumo de água. Uma política robusta de recuperação de áreas de preservação permanente aliada ao reflorestamento de áreas nativas para complementar o ciclo.
Citei um exemplo da questão hídrica, mas devemos nos preparar para todo tipo de desequilíbrio nos próximos anos. Vale lembrar dos grandes incêndios que nos assolaram no ano passado, com grandes prejuízos por perdas de canaviais e com baixas produtividades que estão refletidos inclusive nesta safra. Daqui para frente teremos de ter brigadas de incêndios profissionais e específicas.
Pragas e doenças também estão nessa nova realidade das mudanças climáticas, pois estão surgindo novas e perigosas espécies adaptadas, que até então não nos afetavam e que agora têm de estar no nosso radar. Um bom exemplo é a mosca-deestábulo, praga da pecuária que se adaptou e agora está causando prejuízos e nos dando uma grande dor de cabeça.
Somos um setor estratégico nessa nova realidade de eventos climáticos, uma vez que produzimos um combustível renovável e limpo, que é uma das principais soluções para a descarbonização de nosso planeta. Além disso, somos um dos setores que mais preservam o meio ambiente, com programas e práticas robustas de Sustentabilidade, sendo exemplo para os demais setores e para o mundo. Temos de nos adaptar e agir o mais breve, pois muitas de nossas ações atuais definirão o futuro das próximas gerações.


Gerente Corporativo de Sustentabilidade do Grupo Coruripe
Gerente Corporativo de Sustentabilidade do Grupo Coruripe
Bertholdino
“O homem argumenta, a natureza age.”
Voltaire
São centenas de comentários diários dos políticos e acadêmicos sobre o senso de urgência com relação aos riscos das mudanças climáticas. Vão desde Arnold Schwarzenegger (“As alterações climáticas não são ficção científica. Esta é uma batalha no mundo real com impacto em nós neste momento”) a António Guterres, da ONU (“Chega de maltratar a biodiversidade. Chega de nos matarmos com o carbono. Chega de tratar a natureza como lixo. Basta de queimar, perfurar e minar cada vez em maior profundidade. Estamos cavando nossa própria cova.”). Segundo o Presidente da França (Macron): “Estamos perdendo a corrida para as mudanças climáticas. Esse é o desafio de nossa geração: ganhar a batalha contra o tempo ”; mas segundo o Presidente dos EUA (Trump): “As mudanças climáticas são a maior farsa já perpetuada no mundo.”
A União Europeia, que saiu na frente de todos os países com o seu “ Green Deal” e pressões ambientais, vê os agricultores e seus vários governos fazê-la recuar das suas posições mais radicais. Assim, passo a passo, a realidade vai se impondo.
No Brasil, entre os extremos que politicamente debatem a questão, há um consenso (maioria) de que é fundamental persistir no combate ao aquecimento global, com o agro como chave para esse fim, na reunião da COP 30 a ocorrer em Belém do Pará em novembro/25.
Já há anos o Brasil privado debate com o governo federal medidas voltadas à sustentabilidade, como pedaço fundamental da biocompetitividade, que abraça a produtividade e a mitigação (via adaptação e tecnologias) das emissões dos gases do efeito estufa. De fato, o Brasil agroindustrial, com o etanol, o biodiesel e a bioeletricidade, juntamente com as hidrelétricas, mostra uma matriz energética (50% renovável) e uma elétrica (90% renovável) invejáveis ao mundo desenvolvido e emergente. A integração lavoura/pecuária/floresta adiciona, agora, as biorefinarias, agregando valor.
Globalmente falando, o enfraquecimento da ONU e da OMC vem frenando a velocidade da transição energética, bem aquém do que é preciso, com argumentos crescentes de adição energética (não transição energética) e de crescentes investimentos em energias fósseis, além das renováveis. Isso não segura a meta do +1,5 °C (já estaria hoje acima disso) e se traduz em crescentes riscos ambientais.
Adia-se, com isso, o processo de substituição dos combustíveis fósseis, nas metas definidas para a redução das emissões de gases do efeito estufa. A lógica do forte aumento no consumo de energia pelas tecnologias da inteligência artificial é um fator-chave para as dificuldades de substituição das energias fósseis.
Muitas são as projeções de possíveis tremendos impactos negativos das mudanças climáticas e esse texto aborda o setor sucroenergético e suas medidas para aliviá-las.
As safras canavieiras dos últimos 10 anos mostram (como sempre foi) anos diferentes, mas com um processo constante e repetitivo de secas, acompanhadas de tempos em tempos por geadas e incêndios nas lavouras muito secas. As últimas 15 safras mostram, pelo menos, 6 graves eventos de secas, incêndios e geadas, em ritmo bem maior do que se via antes.
Isso tem levado o produtor de cana da região Centro-Sul e do Norte-Nordeste a procurar na irrigação o foco de investimentos que buscam reduzir a volatilidade de oferta de matéria-prima, assim como viabilizar produtividades que permitam maiores margens, face a boas taxas de retorno a esse investimento em tecnologia.
Outra ação que claramente vai sendo efetivada é a busca de integração agroindustrial, com lavouras em rotação e com a nova onda da produção de etanol com cana e milho em fábricas integradas, gerando subprodutos de alto valor, seja para energias (biogás, biometano) ou para a produção de carnes (DDGs).
A estruturação das empresas setoriais aos controles do fogo já é um esforço geral das unidades produtoras e essencial à atividade, com menores riscos.
Como agro, o esforço geral é no sentido de aumentar recursos para financiamento aos investimentos em sustentabilidade e em seguro rural, via mercado de capitais. Esse é o caminho, cuja regulamentação dependerá do grau de proatividade do setor privado e do suporte crucial do Legislativo brasileiro.
Diretor da Canaplan Diretor da Canaplan


A discussão sobre sustentabilidade deixou de ser um adereço e passou a ocupar o centro da estratégia empresarial. O avanço dos eventos climáticos extremos –estiagens prolongadas, chuvas intensas fora de época e ondas de calor – impõe um teste de resiliência a todos os setores produtivos. No caso da bioenergia, esse desafio é ainda mais sensível.
A cana-de-açúcar, base da produção de etanol, açúcar e bioeletricidade, é uma cultura diretamente exposta às variações do clima, e qualquer desequilíbrio hídrico pode comprometer o rendimento agrícola e industrial, com reflexos sociais e econômicos de grande escala. Nesse contexto, as empresas do setor precisam responder a uma pergunta vital: como produzir de forma estável e competitiva em um cenário climático cada vez mais incerto?
A Bevap Agroindustrial, situada em João Pinheiro, Minas Gerais, vem demonstrando que inovação, governança e sustentabilidade podem caminhar juntas na busca por essa resposta. A companhia estruturou um projeto de irrigação em larga escala, 30.000 hectares, que representou um enorme acerto estratégico. O objetivo central foi reduzir a dependência exclusiva das chuvas, mitigando o risco climático e ampliando a longevidade do canavial. Com o fornecimento hídrico controlado, a cultura mantém estabilidade fisiológica, cresce de forma mais equilibrada e suporta períodos de estiagem sem prejuízos relevantes.
Essa escolha estratégica tem produzido efeitos notáveis. A empresa conseguiu assegurar produtividades agrícolas consistentes acima de três dígitos, mesmo em anos de seca severa, quando outras regiões do País registraram forte queda de rendimento. Além disso, a longevidade dos canaviais foi ampliada, reduzindo a necessidade de replantio e, consequentemente, os custos e impactos ambientais associados.
Outro benefício relevante da irrigação está ligado ao controle mais efetivo do ATR (Açúcares Totais Recuperáveis), parâmetro fundamental para a indústria sucroenergética. Por meio das técnicas de dry-off, que consistem em interromper o fornecimento de água em momentos estrategicamente planejados, é possível induzir o acúmulo de sacarose na planta. O resultado é uma curva de ATR mais eficiente, que garante maior previsibilidade industrial, otimiza a programação da safra e contribui diretamente para o aumento da competitividade do setor. Assim, a irrigação transcende a esfera agrícola e passa a ser também uma ferramenta industrial, permitindo que a usina planeje sua moagem com maior racionalidade, reduza perdas e assegure matéria-prima de qualidade superior.
Ao implantar esse modelo, a Bevap demonstra que sustentabilidade é um conceito multidimensional. No eixo ambiental, a irrigação é conduzida com critérios técnicos rigorosos, garantindo o uso racional da água e evitando desperdícios. No campo social, a estabilidade da safra permite preservar empregos e dar previsibilidade a comunidades que dependem da atividade sucroenergética. No aspecto econômico, a previsibilidade de produção e de ATR fortalece a posição da empresa em um mercado altamente competitivo, reduzindo volatilidades e reforçando sua atratividade junto a investidores.
O caso Bevap ilustra de maneira concreta como o setor bioenergético pode se preparar para conviver com a instabilidade climática. Não se trata apenas de adotar tecnologias de ponta, mas de incorporar uma mentalidade de longo prazo que antecipa riscos, investe em soluções robustas e entende a sustentabilidade como pilar estratégico.
As mudanças climáticas não são um evento futuro, mas uma realidade presente. As empresas que souberem interpretar esse cenário e agir desde já terão mais condições de entregar resultados consistentes, gerar valor compartilhado e cumprir o papel de protagonistas na transição para uma economia de baixo carbono. Em João Pinheiro, no coração de Minas Gerais, a Bevap mostra que é possível unir inovação, governança e responsabilidade ambiental para construir resiliência. E deixa uma lição clara: quem investe hoje em sustentabilidade não garante apenas a próxima safra, mas o futuro de toda a cadeia bioenergética.

Presidente do Conselho da Bevap, Presidente do Conselho da Usina Santa Adélia e Conselheiro Independente da Usina Colombo
Presidente do Conselho da Bevap, Presidente do Conselho da Usina Santa Adélia e Conselheiro Independente da Usina Colombo

A realidade climática impõe novos paradigmas ao agronegócio. Períodos prolongados de seca e veranicos, o aumento das temperaturas médias, a ocorrência de geadas em regiões historicamente imunes e eventos de precipitação extrema que resultam em erosões de solo já não são mais projeções futuras, mas elementos concretos e recorrentes na agenda das agroindústrias. O clima, variável crucial e incontrolável do processo produtivo, deixou de ser uma incerteza distante para se tornar um fator de risco direto e imediato, cujos impactos refletem desde o custo de produção na propriedade até a estabilidade da economia global.
Diante deste cenário de volatilidade, a pergunta que ecoa não é se um evento extremo vai ocorrer, mas quando. A resposta das empresas mais preparadas tem sido uma transição de uma postura reativa para uma estratégia proativa de resiliência. O sistema produtivo está aprendendo a driblar as adversidades, e o principal trunfo para isso é o uso intensivo de informações, aliado às tecnologias capazes de mitigar os seus efeitos.
Neste contexto, a base da resiliência está no solo e na planta. Técnicas agronômicas focadas na conservação e na vitalidade do perfil do solo ganham protagonismo estratégico.
• A conservação e sistematização do solo: para ir além da simples construção de terraços, a definição dessas estruturas deve considerar os fatores edafoclimáticos locais (solo, clima, relevo), com o objetivo de aumentar a infiltração de água no solo, reduzindo o escoamento superficial (principal causa de erosão).
• A regeneração da microbiota do solo: a microbiota é a parte vital de um solo vivo, responsável por processos como a decomposição da matéria orgânica e a disponibilização de nutrientes para as plantas, com práticas de uso de inoculantes (como, Bacillus e Rhizobium). Tecnologias modernas, como a análise metagenômica, permitem mapear a microbiota do solo e direcionar com precisão quais bioinsumos são necessários para restaurar seu equilíbrio. Esses bioinsumos fortalecem as plantas, de dentro para fora, para que resistam melhor a pragas, doenças e estresses abióticos.
• O uso de condicionadores de solo à base de matéria orgânica: os compostos orgânicos provenientes de resíduos agroindustriais e biofertilizantes atuam diretamente na estrutura físico-química do solo, promovendo a formação de microporos, que são essenciais para reter a água e torná-la disponível para as plantas durante períodos de déficit hídrico.
• A maximização de um sistema radicular robusto: permitindo que as plantas explorem um volume maior de solo em busca de água e nutrientes em períodos de estresse.
• Uso de sistemas de irrigação inteligente: A irrigação é uma tecnologia de "proteção contra seca", mas também é uma ferramenta estratégica de gestão agrícola, permitindo maior estabilidade da produção, aumento substantivo de produtividade, otimização de recursos através de tecnologias (fertirrigação, agricultura de precisão e redução de perdas), viabilização de práticas agronômicas avançadas e maior longevidade da cultura.
Estas não são mais técnicas alternativas, mas sim pilares centrais de uma agricultura moderna e adaptada ao momento. A boa notícia é que toda essa tecnologia e práticas já estão à disposição do empresário, e a evolução tecnológica, especialmente a Inteligência Artificial (IA), está potencializando sua eficácia, contribuindo de forma decisiva ao:
• Reduzir o tempo de interpretação de dados climáticos, de solo e de planta, integrando grandes volumes de informação;
• Aumentar a criticidade das análises, identificando correlações e padrões invisíveis ao olho humano;
• Antecipar cenários de risco com maior precisão, modelando os impactos de eventos extremos específicos sobre talhões individuais;
• Oferecer maior exatidão nas recomendações, indicando as práticas e o momento exato para sua adoção, do plantio à colheita.
Por fim, é fundamental reforçar que o caminho para a convivência com as mudanças climáticas não está na adoção de soluções isoladas ou baseadas apenas no empirismo. O sucesso dependerá de como as práticas agronômicas consolidadas pela ciência serão integradas e potencializadas pela mais avançada tecnologia. É nessa sinergia entre o conhecimento do solo e o poder dos algoritmos que o setor produtivo encontrará a sustentabilidade e a produtividade necessárias para enfrentar os desafios de hoje e os que ainda estão por vir.


Diretor de Operações da Usina de Açúcar Santa Terezinha
Diretor de Operações da Usina de Açúcar Santa Terezinha
As mudanças climáticas deixaram de ser previsões científicas distantes para se tornarem fatores estruturais da economia atual. O planeta já vive uma nova era de extremos: ondas de calor recordes, secas prolongadas, enchentes e tempestades intensas. No Brasil, o ano de 2024 foi um alerta, o País enfrentou a maior onda de calor já registrada, com impactos diretos sobre produtividade agrícola. Ao mesmo tempo, eventos como enchentes no Sul, estiagens prolongadas no Centro-Oeste e tempestades no Sudeste evidenciaram a vulnerabilidade das cadeias produtivas. Observa-se uma tendência forte de maiores amplitudes climáticas, com eventos mais extremos, oscilando entre anos-safra muito favoráveis e outros desafiadores. Um exemplo claro ocorre na cana-de-açúcar: após uma supersafra em 2023/24, sucedeu-se a safra 2024/25, marcada pelo maior déficit hídrico desde o ano 2000. Esses fenômenos cada vez mais frequentes e intensos desafiam as empresas a repensar sua forma de operar e inovar. Resiliência climática passou a significar muito mais do que adotar práticas sustentáveis; trata-se de preparar sistemas produtivos, logísticos e energéticos para funcionarem sob estresse ambiental.
O agronegócio brasileiro desempenha papel estratégico na transição para uma economia de baixo carbono. Segundo estudo da FGV, a adoção intensiva de tecnologias de alta produtividade na cadeia da cana-de-açúcar pode elevar as emissões evitadas para 178,6 milhões de toneladas de CO₂ por ano até 2042, um aumento de 129% em relação aos níveis atuais, consolidando o Brasil como referência global em descarbonização.
Para as empresas, adaptar-se a esse novo cenário exige planejamento, investimento em inovação e modelos de governança que incorporem risco climático em suas estratégias. Organizações que antecipam cenários de escassez hídrica, transição energética e impactos sobre cadeias produtivas estão construindo vantagem competitiva de longo prazo e os maiores pilares da sustentabilidade agrícola são a ciência e a inovação.
Os programas de melhoramento genético da cana-de-açúcar, liderados por organizações como o CTC, IAC e a Ridesa, desempenham um papel fundamental na inovação do setor sucroenergético brasileiro. Esses centros são motores de inovação, responsáveis pelo desenvolvimento de novas variedades que apresentam maior produtividade e sanidade, maior tolerância ao estresse hídrico e resiliência superior frente às mudanças climáticas. Como exemplo dessa inovação, posso falar com propriedade do nosso programa, que já utiliza ferramentas de melhoramento de precisão apoiadas por Inteligência Artificial, acelerando a identificação e seleção de genótipos superiores, consolidando ganhos de eficiência e sustentabilidade para toda a cadeia.
Apesar dos avanços científicos e tecnológicos promovidos pelo melhoramento genético, a adoção de variedades modernas no campo ainda ocorre de forma lenta. O cenário dos censos dos anos 2000 e 2005 demonstra que apenas 10 variedades dominavam mais de 90% das áreas cultivadas. Já entre 2020 e 2024, observou-se uma evolução no cenário, com o aumento para 23 variedades predominantes; porém, a maior parte dessas variedades ainda corresponde a lançamentos das décadas de 1980, 1990 e 2000. A limitada adoção demonstra que, embora haja disponibilidade de materiais superiores, a transição para um portfólio mais diversificado e moderno de variedades ainda enfrenta obstáculos, como fatores agronômicos, econômicos e culturais dentro do setor produtivo.
A adoção de genéticas modernas, integrando biotecnologia, é essencial para garantir eficiência produtiva diante dos desafios climáticos crescentes. Além de proporcionar variedades mais resistentes e produtivas, capazes de suportar condições ambientais adversas e manter elevados índices de ganho genético, essas tecnologias trazem benefícios diretos ao manejo agrícola. Além da adoção de genéticas avançadas, a diversificação das variedades cultivadas consolida-se como uma estratégia crítica para a competitividade do setor. A seleção de materiais adaptados às condições ambientais e às práticas de manejo específicas de cada região produtora fortalece a resiliência e assegura respostas mais eficientes às particularidades locais. Com a evolução das ferramentas e tecnologias, essa abordagem tende a se tornar cada vez mais customizada, posicionando o setor para enfrentar desafios crescentes e capturar oportunidades de forma sustentável.


Gerente do Programa de Melhoramento Genético do CTC - Centro de Tecnologia Canavieira
Gerente do Programa de Melhoramento Genético do CTC - Centro de Tecnologia Canavieira
As adversidades climáticas brasileiras — secas, geadas, chuvas torrenciais — não são mais eventos extremos, mas a nova normalidade no Centro-Sul. A pergunta disruptiva não é como se preparar para o imprevisível, mas como prosperar na imprevisibilidade permanente, em cenários de volatilidade contínua.
O paradigma atual da sustentabilidade opera sob uma falácia: a crença de que podemos manter modelos lineares em um sistema climático não-linear. Empresas investem em “resiliência”, conceito defensivo que pressupõe o retorno a um equilíbrio anterior. Mas e se esse equilíbrio nunca mais existir? Essa busca incessante por uma estabilidade ilusória pode nos tornar mais vulneráveis, exaurindo recursos e inibindo a inovação crucial.
Minha experiência de segunda geração em uma empresa familiar de 44 safras me ensinou que a verdadeira revolução está na antifragilidade climática: a capacidade de se fortalecer, melhorar e evoluir a partir de choques e estressores ambientais. Diferente da resiliência, que busca resistir e voltar ao estado original, a antifragilidade não apenas suporta a volatilidade, mas a abraça como vantagem competitiva inerente. Ela exige repensar nossos sistemas e estratégias, reconfigurando para prosperar em qualquer cenário de incerteza, transformando cada perturbação em oportunidade de aprendizado e aprimoramento, utilizando a instabilidade como combustível para a evolução.
O meteorologista Luiz Carlos Molion destaca que variações climáticas seguem ciclos naturais complexos, reforçando a ideia de uma volatilidade intrínseca ao sistema terrestre. O setor sucroenergético brasileiro, desde suas origens, tem exemplificado essa adaptação evolutiva. A dependência do clima e do solo moldou uma cultura de intensa pesquisa e manejo adaptativo, buscando mitigar riscos e aproveitar ameaças, forjando um DNA de flexibilidade e inovação.
Enquanto corporações tratam as mudanças climáticas como custos, o setor sucroenergético brasileiro as transformou em um motor para o desenvolvimento. A cana-de-açúcar sequestra CO2; o etanol, um biocombustível limpo, reduz emissões em até 90%. O bagaço gera bioeletricidade; a vinhaça é um potente biofertilizante; e a levedura, aditivo alimentar. Essa circularidade é uma manifestação da antifragilidade, diversificando receitas e otimizando recursos.
A antifragilidade climática exige uma inversão radical: em vez de perguntar “como proteger meus ativos das ameaças?”, questionamos “como meus modelos de negócio podem se alimentar da instabilidade para gerar valor e inovação?”. Secas prolongadas impulsionam a eficiência hídrica, sistemas de irrigação sofisticados e variedades mais resistentes à estiagem. Chuvas excessivas otimizam a biomassa e estimulam tecnologias de colheita avançadas. Variações térmicas levam ao aprimoramento genético da cana. O risco torna-se um gatilho para a evolução, gerando ganhos em cada flutuação.
A experiência sucroenergética demonstra que adversidades climáticas, quando metabolizadas por um sistema antifrágil, geram inovações robustas e eficientes. Isso impulsionou variedades aprimoradas, o uso crescente de bioinsumos e processos que transformam "resíduos" em valiosas fontes de energia e fertilizantes. Cada perturbação climática é um carregador de informações, estimulando pesquisa e desenvolvimento que tornam o setor cada vez mais robusto e adaptável.
A preparação tradicional falha por assumir previsibilidade. A antifragilidade, em contraste, reconhece que a única certeza é a incerteza. Não fazemos apostas em cenários específicos; construímos capacidades flexíveis e sistêmicas que se beneficiam de qualquer mudança. O setor sucroenergético não apenas resiste, mas metaboliza as mudanças, transformando-as em seu próprio crescimento e evolução. Essa postura proativa garante sua relevância e competitividade.
Essa profunda transformação exige coragem para abandonar ilusões de controle. O futuro pertence às empresas que aprendem a extrair energia e aprendizado de cada instabilidade, transformando a volatilidade em propulsora para um planeta mais sustentável e uma economia robusta, criando valor a partir do caos. Essa é a verdadeira essência da prosperidade na incerteza ambiental, um legado que o setor bioenergético brasileiro já começou a construir de forma exemplar.


Diretor Presidente da Alcoeste
Diretor Presidente da Alcoeste
Luís Antonio Arakaki Luís Antonio Arakaki
A São Martinho consolidou-se como referência no setor bioenergético, destacando-se não apenas pela tradição e solidez, mas também pelo pioneirismo na produção sustentável, alicerçado por tecnologia e inovação. Essa trajetória é viabilizada pela estratégia da companhia em produzir o carbono renovável de menor custo, pela performance operacional, lavoura de excelência e alto nível de gestão, posicionando a empresa como referência no desenvolvimento e adoção das melhores práticas de mercado.
Essa jornada é possível e impulsionada por um trabalho bastante organizado, padronizado, com método e processos bem definidos, associados ao intenso e contínuo cuidado com as pessoas por meio de formação técnica, operacional, normativa e comportamental. Juntos, esses fatores possibilitam transformar em realidade uma série de tecnologias, como: a identificação e o uso de materiais genéticos superiores; a integração de todos os manejos; o uso otimizado de irrigação; a administração de bioinsumos e o controle biológico de pragas (representa 85% das ações relacionadas ao tema na empresa); a produção de Mudas Pré-Brotadas (MPB), que promove vigor, sanidade e pureza genética à lavoura; o preparo de solo com canteirão, prática conservacionista com menor revolvimento e que contribui para a redução de emissões de GEE; a rotação de culturas; a manutenção da cobertura vegetal; a recomendação técnica e a aplicação precisa de todos insumos; e a gestão eficiente dos coprodutos industriais na nutrição do canavial, que favorece a economia circular.
A São Martinho trabalha continuamente no desenvolvimento de um conjunto abrangente de tecnologias voltadas ao aumento da rentabilidade sustentável do negócio. Reforçando seu caráter inovador, liderou a mecanização do plantio e da colheita da cana-de-açúcar, além de ser pioneira na adoção do piloto automático. Essa tecnologia trouxe benefícios como o paralelismo das linhas de plantio, controle de tráfego e, mais recentemente, viabilizou o uso de colhedoras de duas linhas – já uma realidade na operação da companhia –, contribuindo de forma expressiva para os benefícios agronômicos e operacionais.
O pioneirismo da São Martinho também está na gestão ambiental, a exemplo do Programa Viva Natureza que, desde 2000, plantou mais de 4 milhões de árvores. Essa e outras ações compõem a jornada de descarbonização, com foco na intensificação da economia de baixo carbono. No pilar social, a companhia avança com o programa Transforma 3000, que visa a inclusão por meio da educação nas comunidades do entorno.
A gestão de dados sempre foi um diferencial da São Martinho. Por meio do Centro de Operações Agrícolas (COA), a empresa integra tecnologias que geram ganhos em toda a cadeia produtiva, como o uso de satélites, drones, automação e robótica agrícola. Com o sensoriamento remoto é feita análise de biomassa, identificação de falhas e monitoramento de pragas, doenças e plantas daninhas; e, com utilização de Inteligência Artificial, é possível agir em tempo hábil para que não ocorram danos à produtividade da lavoura, promovendo uma agricultura de precisão.
A tecnologia também está presente no cuidado com as pessoas e o meio ambiente. Um sistema de monitoramento com câmeras nas cabines dos caminhões utiliza telemetria e IA para avaliar a condução segura e eficiente. Em tempo real, são identificados sinais de alerta avisando tanto o condutor quanto o COA, atuando como um forte aliado de uma operação segura. Câmeras inteligentes distribuídas estrategicamente monitoram a lavoura 24h por dia, prevenindo incêndios e promovendo alta performance no combate, sendo grande aliada na preservação da biodiversidade.
Na São Martinho, a agricultura é norteada por dados e ciência e o foco é a maximização do resultado do todo. Cuidar das pessoas, exercer gestão eficiente e a adoção contínua de tecnologias que mudam o patamar de entrega e amplificam a eficiência dos fatores de produção são as ações que asseguram excelência; e a forte integração agroindustrial e com todas as áreas garante a performance da companhia. Assim, o sucesso da São Martinho é o resultado do trabalho de todos, que contribuem para uma lavoura resiliente, quando as condições são adversas, e responsiva em condições favoráveis. Essa combinação consolida a São Martinho como uma referência em agricultura moderna, sólida e rentável, ou seja, sustentável.


Diretor de Tecnologia e Inovação da Agroindustrial São Martinho
Diretor de Tecnologia e Inovação da Agroindustrial São Martinho
Nos últimos anos, a sustentabilidade tem sido amplamente debatida, e a agricultura tem avançado na adoção de práticas e técnicas que promovem a utilização racional dos recursos naturais. Aliados a um manejo inovador, que busca a otimização da produtividade e a resiliência das lavouras, os novos modelos de cultivo contribuem para a redução das emissões de gases de efeito estufa.
Diferentemente da conservação de solo tradicional, baseada na construção de grandes barreiras (terraços) para conter o fluxo das enxurradas e evitar a erosão, com ampla exigência de mecanização, alto consumo de diesel e intensa movimentação da camada superficial, hoje, o Manejo Integrado do Solo adota práticas menos invasivas. Essa abordagem preserva a camada fértil, rica em matéria orgânica, mantém a atividade biológica e reduz a vulnerabilidade das lavouras, priorizando o uso inteligente dos recursos naturais, sendo possível aumentar a infiltração e escoamento de água de maneira uniforme dentro das lavouras com projetos de sistematização de solo que dispensam terraços. Essa mudança de paradigma impulsiona uma produção mais sustentável e alinhada às demandas ambientais atuais.
Tradicionalmente, o preparo de solo é realizado em 100% da área cultivada. No caso das culturas de grãos, o sistema de plantio direto consolidou-se como prática predominante, trazendo vantagens como a conservação do solo e da umidade. Já na cana-de-açúcar, cultura semiperene e de múltiplas colheitas, o sistema ainda é pouco explorado. Mesmo assim, há alternativas tecnicamente viáveis e sustentáveis, como a rotação de culturas e o preparo e correção de solo localizado e canteirizado, em maior profundidade. Essas estratégias favorecem a construção de um perfil de solo mais estruturado e, com isso, o desenvolvimento de um sistema radicular mais profundo. Com raízes bem estabelecidas, a planta se torna mais eficiente no uso da água e mais resiliente a estresses climáticos. Ao mobilizar menor volume de solo, o método reduz custos, favorece a fixação biológica de nitrogênio e diminui as emissões de gases de efeito estufa. Somado a isso, a busca de fontes de corretivos e condicionadores de solo com maior reatividade e eficiência agronômica reduz as doses aplicadas e eleva o aproveitamento dos insumos.
O emprego de novas tecnologias como a introdução de cultivares mais produtivas e resilientes aumenta a eficiência do sistema produtivo. A alteração do método de plantio de cana também trará um avanço significativo: o sistema tradicional com plantio de colmos demanda grande volume de mudas. Em média, é necessário 20% da área do canavial para formar outro. A transição para métodos mais próximos ao uso de sementes, como o MPB (Muda Pré-Brotada) atual, suas versões aprimoradas ou outras técnicas inovadoras, visa reduzir esse consumo excessivo, garantindo sanidade, rápida atualização do plantel e demanda de equipamentos mais leves para esta atividade.
Nos tratos culturais, drones, sensores, algoritmos de Inteligência Artificial e ferramentas de análise de imagem revolucionam o monitoramento de pragas e plantas daninhas. Essas tecnologias viabilizam tanto o controle em área total, no momento ideal, quanto o controle localizado de precisão, garantindo o uso racional e assertivo de insumos.
Em todas as fases da cultura, o uso de bioinsumos - seja para redução de fertilizantes minerais ou defensivos químicos - já faz parte da rotina agrícola. Este mercado cresce em taxas anuais acima de 10% e com projeções otimistas para os próximos anos.
Na colheita de grãos, é comum a utilização de colheitadeiras que operam em linhas múltiplas para maximizar a eficiência. Na cultura da cana-de-açúcar, observa-se uma rápida evolução para colheita simultânea de duas linhas, frequentemente associada a substituição de transbordos rebocados por tratores para transbordos autopropelidos. Essa inovação reduz pela metade o número de passagens sobre a área, minimizando o pisoteio, o consumo de diesel e as emissões de gases poluentes, consolidando um modelo de produção agrícola mais sustentável, eficiente e ambientalmente responsável.
É nessa convergência entre resiliência climática, inovação tecnológica e circularidade que está a chave para a construção de um modelo econômico regenerativo, capaz de equilibrar desenvolvimento e preservação.


Gerente de Tecnologia Agrícola
Gerente de Tecnologia Agrícola
Corporativo Brasil da Adecoagro
Corporativo Brasil da Adecoagro
Em um mundo em transformação, a sustentabilidade deixou de ser um diferencial competitivo para se tornar uma necessidade urgente em todos os setores produtivos. No caso do setor bioenergético, essa urgência se intensifica diante da realidade das mudanças climáticas. Embora o segmento seja referência em iniciativas de redução das emissões de Gases de Efeito Estufa (GEE), especialmente pela produção de biocombustíveis renováveis, como o etanol, e pela geração de bioeletricidade a partir do bagaço da cana-de-açúcar, a sua dependência direta das condições climáticas expõe o setor a riscos crescentes, como escassez hídrica, geadas e os incêndios em canaviais.
As alterações nos regimes de chuva, a intensificação de períodos de seca e a recorrência de eventos extremos impactam diretamente a produtividade agrícola. Embora a cana-de-açúcar, base da cadeia de bioenergia, seja uma cultura resistente, ela depende do equilíbrio hídrico e de condições climáticas estáveis. Quando esse equilíbrio se rompe, os efeitos se espalham por toda a cadeia: redução na produção, elevação dos custos de adaptação e maior pressão sobre o planejamento estratégico.
Diante desse cenário, a palavra-chave para o setor é resiliência climática. Além de mitigar suas emissões, o desafio agora é conviver com um futuro em que os impactos climáticos já são realidade. Para isso, diversas empresas têm avançado de forma consistente na adoção de estratégias sustentáveis e inovadoras, transformando seus processos para garantir produtividade e competitividade em um ambiente cada vez mais desafiador.
Um dos pilares dessa transformação é a incorporação de tecnologia de ponta. O uso de sistemas baseados em inteligência artificial e big data permite analisar dados climáticos, de solo e de produção em tempo real, possibilitando decisões rápidas e mais assertivas. Plataformas digitais de monitoramento cruzam informações de satélites, estações meteorológicas e sensores instalados no campo, auxiliando na previsão de safras e na antecipação de riscos climáticos.
Outro caminho é a agricultura regenerativa, prática essencial para a conservação do solo e a manutenção da produtividade no longo prazo. A adoção de técnicas como rotação de culturas, uso de adubos orgânicos e manejo racional dos insumos contribui para restaurar a biodiversidade, aumentar a infiltração de água e reduzir processos erosivos. Ao fortalecer a base natural da produção — solo, água e biodiversidade —, esse modelo cria sistemas agrícolas mais capazes de enfrentar pressões climáticas e manter a eficiência produtiva, assegurando alimento, energia e equilíbrio financeiro. Mais do que preservar o ambiente, a agricultura regenerativa promove um sistema resiliente, inovador e menos dependente de condições climáticas ideais.
Além disso, a irrigação tem ganhado espaço como resposta prática à irregularidade das chuvas. Sistemas modernos, como a irrigação por gotejamento e pivôs centrais inteligentes, otimizam o uso da água e asseguram que a planta receba a quantidade necessária em momentos críticos do seu desenvolvimento. Em paralelo, o investimento em variedades de cana mais resistentes à seca, ao calor e a doenças amplia a capacidade de adaptação do setor.
Essas ações vão além do campo. Investidores, reguladores e consumidores exigem transparência e estratégias claras de gestão climática, e os relatórios de sustentabilidade já refletem essa tendência ao incluir indicadores de riscos, adaptação e governança.
Nesse contexto, o setor de bioenergia precisa demonstrar não apenas sua capacidade de reduzir emissões, mas também de assegurar a continuidade e a segurança do fornecimento em um cenário cada vez mais imprevisível. A resiliência climática consolida-se, assim, como um eixo estratégico de sobrevivência e posicionamento global.
Mais do que reduzir impactos ambientais, o desafio do setor está em construir sistemas produtivos capazes de se adaptar, responder e prosperar frente às variações do clima e às novas exigências de mercado. A resiliência climática é hoje um vetor de inovação do setor — e quem investir agora em adaptação colherá, no futuro, os frutos de uma bioenergia mais sustentável, segura e competitiva.


Gerente de Sustentabilidade da Lins Agroindustrial
Gerente de Sustentabilidade da Lins Agroindustrial
O agronegócio brasileiro sempre foi marcado por sua capacidade de se reinventar e responder com agilidade aos desafios impostos pela natureza, pelo mercado e pela sociedade. Nos últimos 50 anos, o País se tornou referência mundial na produção de alimentos, fibras e energia renovável, sobretudo pela ciência aplicada ao campo, que viabilizou a tropicalização de cultivos, o desenvolvimento de novas tecnologias de manejo e o melhoramento genético vegetal e animal. Porém, o que se observa no presente é uma mudança de escala: se antes as inovações demandavam anos, até décadas, para chegar ao mercado, hoje a velocidade das implantações é fator estratégico para a competitividade e para a sustentabilidade da produção.
No centro dessas transformações, a pesquisa tem atuado na construção de sementes cada vez mais resilientes, capazes de enfrentar estresses hídricos, pragas e doenças com maior eficiência. O objetivo é duplo: ampliar o potencial produtivo e aumentar o valor nutricional, sobretudo proteico, dos alimentos. Em um mundo onde a demanda por proteínas cresce de forma acelerada, atender a esse desafio é vital para garantir segurança alimentar global.
Contudo, há um ponto que não pode ser negligenciado: a democratização dessas inovações. Não basta que sementes mais eficientes e produtivas fiquem restritas às grandes propriedades, com maior acesso a recursos tecnológicos e financeiros. A base da produção nacional está nas mãos de milhões de pequenos e médios produtores, homens e mulheres que sustentam o abastecimento interno, garantem diversidade produtiva e movimentam economias locais. Sem incluir esse público no acesso às inovações, cria-se um hiato que compromete tanto a competitividade do setor quanto o equilíbrio social no campo.
Nesse cenário, as startups do agro, conhecidas como agtechs , ganham protagonismo. Essas empresas emergentes têm desenvolvido soluções tecnológicas escaláveis e acessíveis, pensadas para quebrar as barreiras tradicionais da adoção tecnológica. Sensores de baixo custo, aplicativos de gestão da propriedade, plataformas de rastreabilidade, soluções de irrigação inteligente e bioinsumos adaptados às condições locais são alguns exemplos de como a criatividade empreendedora vem-se traduzindo em instrumentos de democratização da inovação. Diferentemente de modelos tradicionais, em que o custo inicial e a complexidade técnica eram impeditivos, as startups têm-se dedicado a alternativas que qualquer produtor possa utilizar, independentemente do porte da propriedade.
A inovação no agro não ocorre de forma linear, mas em rede. Universidades, centros de pesquisa, cooperativas, associações de produtores e empresas precisam atuar em sinergia para acelerar o tempo de maturação das tecnologias. Em São Paulo, numa iniciativa da Embrapa, com forte apoio da Federação da Agricultura e Pecuária do Estado de São Paulo (Faesp), criou-se um corredor que conecta São José dos Campos a Ribeirão Preto, incluindo institutos, universidades e centros de pesquisas de Campinas, São Carlos e Piracicaba. E, nessa proposta de fomentar as inovações, o Senar está construindo oito centros de excelência: Cana-de-Açúcar e Bioenergia, em Ribeirão Preto; Inteligência Artificial e Turismo Rural, em São Roque; Agricultura Familiar, no Mirante do Paranapanema; Irrigação, em Jaguariúna; Agroindústria, em Avaré; Cacau e Banana, em Miracatu, no Vale do Ribeira; Cacau e Seringueira e de Genética Bovina, em São José do Rio Preto; e de Agricultura Urbana, na capital. No futuro próximo, o ritmo de implantação de inovações tende a ser ainda mais acelerado, impulsionado pela Inteligência Artificial, pela biotecnologia avançada e pela agricultura de precisão em larga escala. Mas o êxito desse processo não será medido apenas pela capacidade de gerar soluções tecnológicas, e sim pela capacidade de torná-las inclusivas. Em outras palavras, o avanço do agro brasileiro dependerá menos da inovação em si, e mais da velocidade com que essa inovação se torna acessível e aplicável a todos os produtores. Esse será o diferencial competitivo que separa países que lideram a revolução agroalimentar daqueles que permanecem na retaguarda. No caso brasileiro, a combinação de ciência de ponta, startups visionárias e inclusão dos pequenos produtores tem todos os elementos para transformar o campo em um laboratório vivo de inovação com resultados concretos para a economia, para o meio ambiente e para a sociedade.



Presidente do Sistema Faesp/Senar
Presidente do Sistema Faesp/Senar
Nos últimos anos, temos presenciado um aumento expressivo na frequência e intensidade dos eventos climáticos extremos. Ondas de calor, estiagens prolongadas, tempestades e enchentes já não são acontecimentos isolados, mas tornaram-se uma realidade que afeta diretamente comuni dades, economias e, em especial, o setor produtivo.
Esse cenário nos impõe uma responsabilidade incontornável: adaptar e planejar o futuro com foco em sustentabilidade e resiliência climática. Mais do que mitigar riscos, cabe às empresas as sumir um papel ativo na construção de um modelo econômico capaz de prosperar em harmonia com os limites da natureza. No setor sucroenergético, essa realidade é ainda mais evidente. Nossa atividade depende diretamente das condições ambientais. Por isso, ações como o uso racional da água, a eficiência energética, o aproveitamento integral da biomassa, a recuperação de áreas degradadas e a incorporação de tecnologias limpas não são mais diferenciais, mas sim condições fundamentais de continuidade.
Na Viralcool, compreendemos que sustentabilidade não é apenas uma pauta ambiental, mas uma estratégia de negócio de longo prazo. Investir em inovação, em práticas responsáveis e em prevenção significa garantir a continuidade das operações e, sobretudo, contribuir para um futuro mais equilibrado para as próximas gerações. Nosso compromisso está alinhado aos 17 Objetivos de Desenvolvimento Sustentável (ODS), da ONU, e integra a nossa estratégia corporativa: eficiência, produtividade e responsabilidade socioambiental caminham juntas. Trabalhamos com indicado res de gestão que nos permitem mensurar resultados, projetar avanços e melhorar continuamente.
A Viralcool também trabalha com a Cyan Analytics (ou Cyan Agro), uma empresa que trabalha com inteligência climática e operacional voltada ao agronegócio. Eles oferecem soluções para mo nitoramento climático, previsão, alertas e análises que apoiam tomadas de decisão em operações agrícolas, com foco em reduzir riscos e otimizar recursos.
O Projeto Cyan permite uma tomada de decisão mais assertiva no campo (plantio, colheita, aplicações, frentes de trabalho), já que é possível programar melhor quando realizar essas ativi dades, reduzindo perdas e riscos, pois o clima pode corresponder por até 50% da produtividade.
Com o monitoramento de incêndios via satélite, ajuda a detectar focos rapidamente, evitando danos ambientais, riscos legais (processos ambientais) e perdas de lavoura. O uso dessas tecnolo gias pela Viralcool mostra como ferramentas climáticas e de monitoramento digital já não são só “extras”: elas passam a ser centrais para produtividade, mitigação de riscos e sustentabilidade. Ao integrar dados de previsão, satélite, NDVI, alertas, a empresa consegue operar de forma mais pre cisa, reagir antecipadamente a eventos climáticos adversos, proteger o meio ambiente e otimizar seus recursos. Mas entendemos que sustentabilidade vai além dos muros da empresa: é também um compromisso com a sociedade. Por isso, desenvolvemos programas que envolvem colabora dores e comunidades:
• Projeto Plantando o Futuro – mais de 120 espécies cultivadas em nosso viveiro e mais de 50 mil mudas produzidas por ano, destinadas à recuperação de áreas de preservação, reflorestamentos municipais, fornecedores e colaboradores.
• Campanha Juntos pelo Meio Ambiente – em parceria com o Zoo Sonho de Criança, aproximamos famílias e comunidades da educação ambiental por meio de experiências lúdicas e de conscientização sobre preservação.
• Campanha Viralcool Contra o Fogo – levamos às escolas municipais e estaduais projetos de prevenção e combate a incêndios, formando jovens conscientes sobre o valor do meio ambiente.
• Programa Nascentes para o Amanhã – dedicado à recuperação e preservação de nascentes em nossas áreas e em parcerias, garantindo água limpa para córrego
Essas iniciativas demonstram que a sustentabilidade é vivida de forma prática e contínua den tro da Viralcool.
Os eventos climáticos são um desafio global. As empresas que souberem se antecipar estarão não apenas mais preparadas para manter sua competitividade, mas também para conquistar le gitimidade social.
Na nossa visão, sustentabilidade é, acima de tudo, sinônimo de visão de futuro. E é com essa consciência que seguimos conduzindo nossas atividades, certos de que cada decisão tomada hoje terá reflexos diretos no amanhã.



Diretor Agrícola da Virálcool
Diretor Agrícola da Virálcool




Anuário de Sustentabilidade do sistema Bioenergético




























Trabalho de acompanhamento da fauna faz parte de uma estratégia que alia produção agrícola à responsabilidade ambiental
Levantamento realizado entre 2010 e 2025 aponta alta biodiversidade na Área de Influência Direta (AID) da Alcoolvale, em Aparecida do Taboado-MS, com valores expressivos nos últimos 15 anos. O relatório, que monitora a fauna local, mostra que o número de espécies registradas é bastante alto e vem aumentando de forma consistente, sinalizando melhorias na conservação ambiental e na qualidade dos ecossistemas da região.
Segundo os dados, já foram identificadas 390 espécies de fauna, distribuídas entre aves, mamíferos, répteis, anfíbios e peixes. A biodiversidade local vem sendo bem descrita desde o início do projeto: aves: de 171 espécies em 2010 para 266 em 2025; mamíferos: de 21 em 2010 para 32 em 2025, répteis: de 26 em 2010 para 52 em 2025; e anfíbios: de 20 em 2010 para 40 em 2025.
De acordo com o Departamento de Meio Ambiente da Alcoolvale, responsável pelo monitoramento, estes números indicam não apenas a eficácia das medidas de mitigação e recuperação ambiental, mas também a capacidade de resiliência dos ecossistemas locais, mesmo diante das pressões da atividade agrícola.
O relatório também chama atenção para a presença de animais considerados “espécies-chave”, cujo papel ecológico é fundamental para a manutenção do equilíbrio ambiental. Entre eles estão:
•Tamanduá-bandeira (Myrmecophaga tridactyla): classificado como vulnerável à extinção e importante no controle de populações de insetos.
•Lobo-guará (Chrysocyon brachyurus): dispersor de sementes e indicador da saúde do Cerrado.
•Cervo-do-pantanal ( Blastocerus dichotomus ): herbívoro nativo que influência a dinâmica da vegetação nos brejos e várzeas.
• Jaburu (Jabiru mycteria): ave típica de áreas úmidas, muito sensível à qualidade hídrica.
•Papagaio-verdadeiro (Amazona aestiva): espécie protegida com relevância para a regeneração florestal.
A ocorrência desses animais reforça o papel da AID como refúgio ecológico e ressalta a importância da manutenção de programas contínuos de monitoramento.


A Alcoolvale identifica, monitora e ainda leva informação para a sociedade. Como desdobramento desta ação, a empresa promoveu, em junho deste ano, uma série de palestras educativas voltadas para alunos do Ensino Fundamental de Aparecida do Taboado, alcançando mais de 600 estudantes. Imagens de animais capturadas com câmeras "trap", ins -
taladas nas áreas de mata próximas à empresa, despertaram a curiosidade dos alunos e ampliaram o conhecimento sobre a biodiversidade local. "Acreditamos que desta forma, unindo conservação e educação ambiental, colaboramos para proteger a biodiversidade do Cerrado", finalizam os responsáveis pelo departamento de Meio Ambiente.

Criada nos anos 1960, a liga de Bronze TM23 permanece em uso quase essencial para atender às exigências técnicas do setor sucroenergético, renovável do Brasil
De acordo com o Balanço Energético Nacional 2024, elaborado pela Empresa de Pesquisa Energética, a cana-de-açúcar responde por 16,9% da oferta interna de energia do Brasil e continua sendo a principal fonte renovável da matriz energética nacional. Esse protagonismo coloca o setor sucroenergético em posição estratégica para a economia, ao mesmo tempo em que amplia os desafios industriais ligados à operação de equipamentos submetidos a condições severas de pressão, corrosão e atrito.
Para manter a competitividade, foi necessário desenvolver soluções técnicas que garantissem durabilidade, eficiência e confiabilidade em processos de grande escala. Nesse contexto, a trajetória do Bronze TM23 se tornou emblemática, já que a liga desenvolvida pela Termomecanica nos anos 1960 permanece, quase seis décadas depois, como um componente fundamental das usinas de cana.

Da ancestralidade às ligas industriais
O uso do Cobre e de suas ligas acompanha a humanidade desde a Antiguidade. Povos egípcios e mesopotâmicos identificaram que a adição de pequenas quantidades de estanho ao Cobre resultava em um material de fusão mais simples e com maior resistência mecânica, o Bronze, que rapidamente se disseminou para a fabricação de ferramentas, armas, adornos e instrumentos de trabalho.
O simbolismo atribuído ao metal na cultura egípcia, representado pelo “Ankh”, a cruz com alça que remete à vida, mostra como sua durabilidade se conectava à própria ideia de perenidade. Séculos depois, com a Revolução Industrial, o desenvolvimento de novas ligas metálicas ganhou intensidade. A modernização das máquinas exigia composições específicas, capazes de suportar esforços mecânicos cada vez mais exigentes, o que impulsionou a pesquisa metalúrgica em várias partes do mundo.


contribui
seis décadas depois e segue pilar da matriz energética
A chegada do Bronze TM23
No Brasil da década de 1960, o Engenheiro Salvador Arena, fundador da Termomecanica, identificou que as ligas de Bronze disponíveis para mancais de deslizamento eram numerosas, mas apresentavam pouca diferença prática entre si. Os resultados em operação não atendiam plenamente às necessidades de resistência e durabilidade que a indústria exigia.
Diante desse cenário, Arena iniciou um trabalho sistemático de pesquisa, com uma série de ensaios laboratoriais que buscavam encontrar a composição ideal. Após sucessivas tentativas, o vigésimo terceiro teste alcançou os resultados esperados, combinando desempenho mecânico superior e estabilidade em condições adversas. Dessa experiência surgiu o Bronze TM23, uma liga que se diferenciou das demais e que rapidamente passou a ser reconhecida pelo mercado pela confiabilidade.
A consolidação desse desenvolvimento ocorreu alguns anos depois, em meio à transformação exercida pelo Programa Nacional do Álcool, o Proálcool, lançado em 1975. A expansão da produção de etanol demandava usinas maiores, com moendas capazes de processar volumes crescentes de cana

e submetidas a esforços de atrito, corrosão e pressão muito mais severos do que até então. O desafio técnico impunha a necessidade de ligas robustas, com vida útil ampliada e desempenho confiável.
A partir disso, em 1979, a Termomecanica lançou sua linha de Capas de Bronze para moendas, utilizando o TM23 em escala industrial. Os resultados demonstraram que a liga respondia adequadamente às novas exigências, tornando-se rapidamente referência para o setor.
Impacto duradouro
A durabilidade das peças fabricadas com TM23 é um dos fatores que consolidaram sua relevância. Estudos técnicos e relatos de campo indicam que, quando as Capas de Bronze são instaladas corretamente, com alinhamento adequado e processos de lubrificação e refrigeração eficientes, é possível utilizá-las por mais de uma safra. Esse desempenho prolongado significa menos paradas para manutenção, menor necessidade de reposição de componentes e redução de custos operacionais para as usinas.
Além do impacto direto na eficiência produtiva, há reflexos ambientais importantes, já que a maior vida útil das peças reduz a demanda por novas matérias-primas e por energia destinada à fabricação de substituições, contribuindo para um modelo industrial menos intensivo em recursos.
Criada em um momento de busca por soluções para mancais de deslizamento, a liga se adaptou a novas demandas e atravessou diferentes ciclos da economia brasileira, mantendo-se relevante diante de transformações tecnológicas e produtivas. Sua permanência no setor sucroenergético, mesmo após quase seis décadas, reforça a importância de processos de inovação que respondem a necessidades concretas e que se sustentam no tempo.
Em um cenário atual marcado pela transição energética e pelo esforço global de reduzir emissões de carbono, o papel do etanol e da cana-de-açúcar na matriz brasileira ganha ainda mais visibilidade. A eficiência dos equipamentos industriais que viabilizam essa produção é parte essencial da equação, e ligas como o Bronze TM23 continuam a oferecer suporte a esse processo. O legado do desenvolvimento realizado pela Termomecanica, por meio de seu fundador, demonstra que a combinação de conhecimento técnico, capacidade de pesquisa e aplicação prática pode gerar soluções industriais com impacto duradouro, fortalecendo não apenas um setor específico, mas a própria competitividade da economia nacional.


A Usina Atena, comprometida com o desenvolvimento sustentável e a conscientização ambiental, realizou neste ano a sexta edição do Projeto Semeando, uma ação que simboliza o compromisso da empresa com o futuro das próximas gerações.
Mais do que um simples plantio de mudas, o projeto é uma verdadeira experiência de educação ambiental, unindo aprendizado, sensibilização e ação prática. Realizado anualmente em comemoração ao Dia da Árvore, o Semeando promove o plantio de espécies nativas em áreas de preservação permanente e reservas ambientais dentro da unidade da Usina Atena. A iniciativa reforça o papel da empresa como guardiã dos recursos naturais e multiplicadora de conhecimento ambiental junto à comunidade local.
Desde sua criação, o Semeando tem como objetivo envolver crianças no processo de restauração ambiental, despertando neles o sentimento de pertencimento e responsabilidade com o planeta. Para isso, o projeto conta com uma importante parceria: as escolas municipais dos municípios de Rancharia e Martinópolis, que anualmente participam das atividades junto à equipe da usina.
Cada edição é marcada pela presença de novas turmas e escolas convidadas,
ampliando o alcance do projeto e permitindo que mais alunos vivenciem a experiência de plantar uma árvore — um gesto simples, mas carregado de significado.
Em 2024, o projeto ganhou um reforço especial: a participação da APAE de Martinópolis, que se integrou à iniciativa com entusiasmo e sensibilidade. A presença dos alunos da instituição trouxe ainda mais significado à ação, reforçando a inclusão e o papel transformador da educação Ambiental.


Neste ano, com a realização da sexta edição, o Semeando se consolida como uma tradição na agenda ambiental da Usina Atena e um exemplo de como o setor produtivo pode atuar de forma ativa na promoção da sustentabilidade.
A cada nova etapa, o projeto cresce — assim como as árvores que já foram plantadas ao longo dos anos — e renova o compromisso da empresa com a preservação dos recursos naturais e a conscientização das futuras gerações.
O impacto do projeto vai muito além da área plantada. Ele se reflete na mudança de comportamento e na formação de uma consciência coletiva voltada para o cuidado com o meio ambiente.


São centenas de mudas nativas plantadas e, principalmente, centenas de jovens cidadãos mais conscientes sobre o papel de cada um na construção de um mundo mais verde.
O maior legado do projeto talvez seja o de semear esperança. Cada criança que participa leva consigo a experiência de plantar algo que crescerá com o tempo, lembrando que cuidar do meio ambiente é uma tarefa contínua.
A cada árvore que floresce, floresce também a consciência de que a preservação é responsabilidade de todos. E é justamente nesse florescer conjunto, entre natureza e sociedade, que o Projeto Semeando encontra sua força e sua beleza.

Stolthaven Terminals
R. Augusto Scaraboto, 215 - Alemoa / Santos / São Paulo / Brasil
CEP: 11095-500 - Tel.: 55. 13. 3295.9000
Subsidiária da Stolt-Nielsen Limited.
Eventos climáticos extremos estão moldando os mercados globais. A Stolthaven Terminals se antecipa a esse cenário com infraestrutura robusta e flexível para armazenar e distribuir produtos estratégicos — de biocombustíveis a insumos essenciais.
Com certificações internacionais e operações de excelência, estamos preparados para garantir segurança, continuidade e sustentabilidade em um mundo cada vez mais desafiador.



Escaneie o QR code e acesse o nosso site para conhecer nossos serviços premiados internacionalmente.


Em um mundo em constante transformação, onde a produtividade e a tecnologia avançam em ritmo acelerado, a verdadeira sustentabilidade das empresas se mede também pela capacidade de cuidar das pessoas. Na Usina Jacarezinho, empresa pertencente ao Grupo Maringá, a saúde e o bem-estar dos colaboradores ocupam lugar central na estratégia de sustentabilidade. A empresa entende que não há futuro possível sem o equilíbrio físico, mental e social de quem faz o negócio acontecer.
Nos últimos anos, a Usina vem consolidando uma cultura organizacional baseada na valorização humana e no cuidado integral, traduzida em ações estruturadas que vão desde o acompanhamento psicoterápico até a prevenção de doenças ocupacionais.
Dois projetos que ilustram essa visão: Programa Qualidade de Vida, com foco na saúde e bem-estar corporativo, e a ação de Prevenção ao Câncer Bucal em Trabalhadores Rurais, desenvolvida em parceria com a Universidade Estadual do Norte do Paraná (UENP).

Programa Qualidade de Vida: um compromisso coletivo
O Programa Qualidade de Vida, criado em 2024, surgiu como resposta estruturada aos desafios contemporâneos do mundo do trabalho. Com base em um diagnóstico participativo — realizado por meio de rodas de conversa entre lideranças e equipes multidisciplinares —, a empresa construiu um plano de ação para promover o bem-estar físico e emocional dos colaboradores.
Entre as iniciativas, destacam-se campanhas de conscientização, palestras sobre saúde financeira, rodas de conversa e a ampliação dos atendimentos psicoterápicos subsidiados integralmente pela organização — agora estendidos também aos dependentes. A inclusão da plataforma Wellhub, que oferece acesso a academias, reforça o incentivo a hábitos saudáveis fora do ambiente de trabalho.
A capacitação das liderança em Segurança Psicológica foi outro marco importante. Ao estimular um ambiente em que todos se sintam seguros para expressar ideias e emoções, a empresa fortalece uma cultura de confiança, diálogo e acolhimento.
O resultado é perceptível: clima organizacional mais saudável, redução de afastamentos e maior engajamento das equipes.
A criação do Programa Qualidade de Vida foi um passo importante para a consolidação do valor que a organização confere à saúde do colaborador, bem como instituir um time multidisciplinar consolidar a visão estratégica do assunto.
Saúde bucal no campo: prevenção que transforma

No mesmo propósito de cuidar de quem faz parte da sua história, a Usina Jacarezinho também atua na saúde preventiva dos trabalhadores rurais, e nos aspectos de saúde que impactam na sua jornada. Em parceria com a UENP, o time do Ambulatório Médico da Usina promoveu uma ação de triagem e educação em saúde bucal que atendeu 130 colaboradores rurais.
A iniciativa combinou palestras educativas, orientações sobre fatores de risco (como tabagismo, etilismo e exposição solar) e avaliações clínicas realizadas dentro da própria empresa. O resultado foi expressivo: 99 trabalhadores foram encaminhados para tratamento odontológico.
Mais do que números, a ação reforçou o poder das parcerias entre empresa e universidade e demonstrou como a educação em saúde pode gerar impacto direto na qualidade de vida, prevenção e diagnóstico precoce — elementos essenciais da sustentabilidade humana.
Sustentabilidade que começa pelas pessoas
A trajetória da Usina Jacarezinho mostra que sustentabilidade é ampla vai nos âmbitos produtivos, ambientais e — principalmente — uma gestão do cuidado com as pessoas. Ao integrar saúde física, mental e ocupacional, a empresa reafirma seu compromisso com os Objetivos de Desenvolvimento Sustentável (ODS), especialmente os de número 3 (Saúde e Bem-Estar) e 8 (Trabalho Decente e Crescimento Econômico).
O futuro sustentável é construído por pessoas saudáveis, motivadas e respeitadas. E é com essa convicção que a Usina Jacarezinho segue ampliando seus programas de qualidade de vida, fortalecendo o vínculo entre propósito, produtividade e cuidado humano — porque cuidar das pessoas é, também, cuidar do planeta e do negócio.

TECNOLOGIA E INOVAÇÃO NA GERAÇÃO DE VAPOR anos

Eficiência e Sustentabilidade:
Com foco em inovação e sustentabilidade, a DanPower, fabricante brasileira de caldeiras sediada em Piracicaba (SP), vem se destacando no setor de geração de energia ao desenvolver tecnologias próprias que combinam alta performance e respeito ao meio ambiente.
Entre suas principais soluções estão as grelhas vibratórias e os precipitadores eletrostáticos, equipamentos que refletem o compromisso da empresa com eficiência, durabilidade e redução de impactos ambientais.



Pioneira no Brasil na fabricação de caldeiras com grelha vibratória 100% nacional, a DanPower desenvolveu uma tecnologia robusta e versátil, capaz de operar com diferentes tipos de biomassa, inclusive com alto teor de umidade — até 60% — sem perda de eficiência.
A refrigeração a água, integrada ao próprio sistema da caldeira, garante estabilidade térmica, longa vida útil e disponibilidade operacional acima de 98%. Além disso, o sistema dispensa componentes fundidos, reduzindo custos de manutenção e simplificando a operação.
Comparada ao leito fluidizado, a grelha vibratória consome menos energia, dispensa areia e não requer combustíveis fósseis para partida, resultando em maior economia e sustentabilidade. Essa tecnologia já está presente em dezenas de projetos no Brasil, atendendo setores como sucroenergético, químico, alimentício, papel e celulose, destacando-se pelo desempenho e confiabilidade.

Com foco na redução de emissões e preservação ambiental, os precipitadores eletrostáticos DanPower garantem níveis extremamente baixos de particulados nos gases de exaustão, atendendo às legislações mais rigorosas do setor.
O processo utiliza a força eletrostática para atrair e reter partículas, que são removidas de forma seca, sem o uso de água. Isso representa um grande avanço ambiental: enquanto lavadores de gases consomem cerca de 2 m³ de água por tonelada de vapor gerado, os precipitadores eliminam essa necessidade, preservando recursos hídricos e reduzindo custos operacionais.
Fabricados em aço carbono e equipados com eletrodos emissores, coletores, sistema de batimento automático e moegas de cinzas, os precipitadores oferecem alta eficiência de retenção, operação contínua e baixa manutenção, evitando incrustações, corrosões, erosões nos exaustores, dutos e chaminés.
Engenharia Integrada para um Futuro Sustentável
A combinação entre grelhas vibratórias e precipitadores eletrostáticos reflete a filosofia da DanPower: desenvolver soluções completas e sustentáveis para o setor energético. Enquanto a grelha vibratória garante eficiência na combustão e aproveitamento de biomassa, o precipitador assegura que o processo ocorra dentro dos mais altos padrões de controle ambiental.
Com engenharia própria, equipe de 340 colaboradores e experiência consolidada em todo o território nacional, a DanPower reafirma seu compromisso em oferecer tecnologias que unem confiabilidade, eficiência e responsabilidade ambiental, preparando o setor para os desafios de um futuro de baixas emissões.

Primeira lavoura do grão voltada à produção de etanol é colhida no Sertão do estado e recebida na Usina Pindorama
A Pindorama revolucionou o setor sucroenergético nordestino ao lançar a primeira usina flex da região. Agora, revoluciona através do incentivo ao cultivo do sorgo em Alagoas.
Na sexta-feira, dia 3 de outubro, o que era ideia se fez na prática, com a colheita de 11 hectares de sorgo, no município de Batalha, e transporte de cerca de 60 toneladas do grão para a Usina Pindorama. É a primeira colheita de sorgo para produção de etanol em terras alagoanas.
Esta semente começou a dar frutos através de uma parceria firmada com a Latina Seeds, em evento realizado em 16 de janeiro deste ano, com pequenos e médios produtores rurais de todas as

regiões do estado. Na ocasião, a Pindorama despertou neles o interesse pela cultivo do sorgo granífero.
Dos 11 hectares de terras cultivadas com sorgo na propriedade do produtor rural Manoel Messias Costa, cerca de 60 toneladas de grãos foram colhidas. Esse total foi adquirido pela Cooperativa Pindorama para produção do etanol e, no final do processo, o coproduto WDG, de grande índice proteico e essencial para nutrição animal, principalmente gado leiteiro e de corte.
Segundo o gerente comercial da Latina Seeds para o Nordeste, Thiago Rodrigues, a iniciativa da Pindorama está gerando resultados promissores para Alagoas.



Ele destacou que, com pouco investimento, a lavoura em questão gerou resultados excelentes.
" Uma média de produtividade de mais de 87 sacas por hectare. Uma excelente produtividade para um primeiro plantio, ainda mais com um investimento de médio a baixo custo. Em peso, por hectare, deu mais 5.200 kg. Excelente!", avaliou Rodrigues. O produtor Manoel Messias Costa disse que o plantio foi uma grande conquista, agradecendo à Pindorama e à Latina Seeds pelo apoio.
"Uma grande conquista. Com muito esforço e apoio foi plantado o sorgo da Latina Seeds, com acompanhamento do Thiago Rodrigues e a garantia de compra da Pindorama. Sou o primeiro aqui em Alagoas a fornecer sorgo à Pindorama. Quero agradecer a todo o apoio da Cooperativa em todos os momentos, e ao Thiago Rodrigues, desde o plantio até a colheita" , agradeceu Costa.
O presidente da Cooperativa Pindorama, Klécio Santos, é um dos principais incentivadores do desenvolvimento da cultura do sorgo no estado. Segundo o próprio, trata-se da realização de um objetivo coletivo de busca por mais crescimento.
"Estamos cumprindo aquilo que a gente sempre sonhou, de apoiar, garantir a compra e a logística. Está concretizada a primeira colheita de sorgo no estado de Alagoas para a produção de etanol. Outras virão, estimulando mais uma vertente de geração de emprego, renda e de desenvolvimento para Alagoas" , comemorou Klécio Santos.



A Cooperativa Pindorama sempre apostou em energia renovável e limpa, dando uma importante contribuição junto à política de descarbonização no país. Isso evidencia o DNA de pioneirismo de uma das maiores cooperativas agroindustriais do Brasil, sua preocupação com o meio ambiente, com a preservação dos recursos naturais renováveis e com geração de mais oportunidades para os alagoanos.


✓ Mangueiras e Conexões
✓ Filtros e Equipamentos de Filtragem
✓ Hidráulica
✓ Pneumática
✓ Vedações
✓ Chicotes Elétricos e Sensores SUPORTE E ATENDIMENTO
✓ Equipe técnica especializada
✓ Agilidade na entrega
✓ Projetos e instalações de sistemas de filtragem hidráulica e de combustível
✓ Equipamentos de montagem de mangueiras






C
d e s e n v o l v i m e n t o
h u m a n o e s t á r e d e f i n i n d o a l i d e r a n ç a
e f o r t a l e c e n d o a c u l t u r a
o r g a n i z a c i o n a l e m u m a
d a s e m p r e s a s m a i s
t r a d i c i o n a i s d o s e t o r
s u c r o e n e r g é t i c o .
O q u e c o m e ç o u c o m o u m a i n q u i e t a ç ã o p e s s o a l d u r a n t e u m c u r s o e m
H a r v a r d g e r m i n o u e m s o l o f é r t i l n a U s i n a S a n t a F é E m 2 0 1 9 , o e n t ã o d i r e t o r
a g r í c o l a h o j e C E O t r o u x e p a r a a e m p r e s a u m a p r o p o s t a o u s a d a :
i n t e g r a r o s g e s t o r e s d a á r e a a g r í c o l a p o r m e i o d o a u t o c o n h e c i m e n t o e d a
c o r r e s p o n s a b i l i d a d e A s s i m n a s c e u o p r o g r a m a L í d e r e s e m A ç ã o ,
f i r m e , p r o v a
e q
n d o h á p r o p ó s i t o e c o r a g e m p a r a e v o l u i r



O sucesso da primeira edição inspirou a expansão do programa. Em 2024 , gestores das áreas industrial e administrativa se juntaram à jornada, somando mais 27 par ticipantes E em abril de 2025, todos os grupos se unif icaram, formando um único corpo de liderança com visão compar tilhada e valores alinhados

O programa benef icia não apenas os gestores, mas também os colaboradores e suas famílias Ao promover ambientes mais saudáveis e integrados, a Santa Fé reforça seu compromisso com a sustentabilidade humana um valor tão essencial quanto a ef iciência operacional Líderes em Ação: mais que um programa, um movimento.
A Usina Santa Fé mostra que liderança não é apenas sobre resultados, mas sobre pessoas O programa Líderes em Ação é um convite à transformação pessoal, coletiva e organizacional. E essa jornada está apenas começando





Reconhecimento nacional: Prêmio
MasterCana Social
O impacto do programa Líderes em Ação ultrapassou os limites da Usina Santa Fé ganhou destaque nacional. Em 11 de ag de 2025, a empresa foi agraciada com o Prêmio Excelência em Liderança no MasterCana Social, consagrando o proje como referência em desenvolvimento humano e valorização da liderança no s sucroenergético “Esse reconhecimento f ruto de um extraordinário trabalho em equipe, que reflete nosso compromisso com as pessoas e com a paixão pelo que fazemos.”









Na Usina São José da Estiva, sustentabilidade e responsabilidade social não são apenas compromissos — são parte essencial da nossa identidade. Conectada com a comunidade de Novo Horizonte, a Estiva Bioenergia investe em projetos que transformam realidades, promovem conhecimento e fortalecem vínculos humanos e ambientais.
Um dos projetos que exemplifica esse compromisso é o Meliponário Municipal de Novo Horizonte, criado em parceria com a Associação de Apicultores e Meliponicultores de Novo Horizonte e Região (AAMEL) e a Diretoria Municipal de Meio Ambiente e Urbanismo. A Estiva investiu recursos, conhecimento técnico e mão de obra para tornar o projeto realidade. O espaço abriga abelhas nativas sem ferrão, responsáveis pela polinização de cerca de 80% dos vegetais, e se tornou referência em educação ambiental. Com estrutura adequada e programação voltada para escolas e entidades, o meliponário dissemina conhecimento sobre biodiversidade e reforça a importância da preservação ecológica.
Na área educacional, a Estiva aposta na tecnologia como ferramenta de inclusão e transformação. A oficina "Mentes Curiosas e Robôs Criativos", realizada na Assistência da Usina, oferece aulas de robótica e desenvolvimento de jogos para crianças e adolescentes. Os participantes têm acesso a conteúdo interativo que estimula o pensamento crítico, a resolução de problemas e o trabalho colaborativo.
A robótica incentiva a curiosidade e traz conteúdos que acompanham os alunos para a vida. A iniciativa reforça o compromisso da empresa com a educação do futuro e com a formação de cidadãos preparados para os desafios da era digital. As entidades do município são palcos das atividades culturais e artísticas que valorizam o potencial humano. O projeto "Cultivando Conhecimento" oferece aulas de canto e teclado, contação de histórias, artes cênicas e dança. A Estiva Bioenergia entende que a cultura é uma ferramenta poderosa para a vida. É uma semente plantada para que os participantes desenvolvam criatividade, disciplina e autoconfiança.




As oficinas promovem inclusão, fortalecem vínculos e ampliam horizontes, contribuindo para o bem-estar e o desenvolvimento integral dos participantes.
E quando o assunto é celebrar a união e o encantamento, o Natal Iluminado é um espetáculo à parte. Desde 2022, a Estiva, em parceria com o Grêmio Novorizontino, realiza um evento mágico que reúne milhares de pessoas. A chegada do Papai Noel - sempre surpreendente -, é o ponto alto de uma noite repleta de guloseimas, brinquedos e presentes para as crianças. Em 2024, mais de 5 mil pessoas testemunharam o bom velhinho surgir de um globo iluminado, reforçando o espírito natalino e o sentimento de pertencimento da comunidade.
Cada projeto da Estiva Bioenergia é movido pela crença de que o futuro se constrói com energia, empatia e compromisso. Seja promovendo a educação, preservando o meio ambiente ou celebrando tradições, a Usina São José da Estiva segue firme em sua missão de gerar impacto positivo — porque o futuro é a nossa energia.






Dia Mundial da Água
Em março, a Energética Serranópolis promoveu ações educativas alusivas ao Dia Mundial da Água, destacando a importância do uso racional desse recurso essencial. A programação incluiu painéis, distribuição de materiais e dinâmicas com colaboradores, reforçando que a preservação hídrica é uma prática cotidiana indispensável.
• Quiz Educativo - Preservação da Água:
Para complementar, foi aplicado um quiz interativo com estudantes, abordando o ciclo da água, disponibilidade hídrica e formas de conservação. A atividade aproximou os colaboradores do tema e valorizou a educação ambiental como ferramenta de conscientização.
• Entrevista em Rádio – Combate a Incêndios:
A empresa participou de entrevista na Rádio Serra Verde FM, levando infor-
mações à população sobre prevenção e combate a incêndios florestais no período seco. A ação ampliou o alcance da campanha de conscientização, envolvendo produtores e comunidade em boas práticas preventivas.
• Manejo de Mudas Nativas:
No viveiro, a empresa realiza o manejo de mudas nativas do Cerrado, destinadas à recuperação de áreas degradadas e doação. O processo de seleção e aclimatação garante mudas de qualidade para restauração ambiental.
• Doação de Mudas Nativas:
Em 19/09/2025, a empresa promoveu a doação de mais de 200 mudas no município de Serranópolis, incentivando o plantio de espécies regionais em quintais, áreas urbanas e rurais. A iniciativa fortalece a arborização, a biodiversidade e a sensibilização sobre o papel das árvores no equilíbrio climático.

• Reunião do Condema:
A Energética Serranópolis integra o Conselho Municipal de Defesa do Meio Ambiente (CONDEMA), contribuindo para alinhamentos estratégicos sobre o planejamento ambiental de Serranópolis e fortalecendo a governança participativa.
• Dia Mundial do Meio Ambiente –Coleta Seletiva:
Em 5 de junho, a empresa realizou uma dinâmica de coleta seletiva, reforçando a importância da segregação de resíduos e do descarte adequado. Foram apresentados os 5 Rs da sustentabilidade — repensar, reduzir, reutilizar, reciclar e recusar — incentivando hábitos alinhados à economia circular.
• Produção de Bioinsumos:
Na biofábrica, a empresa investe na multiplicação de bioinsumos para uso agrícola, reduzindo a dependência de químicos e promovendo solos mais saudáveis. A prática reforça a sustentabilidade da cadeia produtiva da cana-de açúcar.
Conclusão:
As ações demonstram o compromisso da Energética Serranópolis com a sustentabilidade integrada, unindo conservação ambiental, engajamento social e inovação tecnológica. Com iniciativas que vão da recuperação de áreas degradadas à produção de bioinsumos, a empresa reafirma seu papel de agente transformador em prol de um futuro mais equilibrado.








A ALFATERM projeta, fabrica e instala torres de resfriamento de água para inúmeros processos industriais há mais de 39 anos, além de realizar manutenção preventiva e corretiva, testes de performance regulamentados e aprovados pelo CTI, reforma e recapacitação de torres, disponibilização de equipamentos para locação e completo estoque de peças de reposição.
Uma gigante no coração do Brasil: 45 Anos de história, transformando biomassa em tuturo
Somos uma das maiores e mais integradas biorrefinarias do Brasil, que há 45 anos transforma matérias-primas renováveis em bioprodutos e bioalimentos.
Acreditamos firmemente na construção de um futuro sustentável. Por isso, toda nossa estratégia é guiada pela Jornada de Sustentabilidade, alinhada aos Objetivos de Desenvolvimento Sustentável (ODS) da ONU e às melhores práticas ESG (Ambiental, Social e Governança). Energia de preservação
BIOENERGIA + AÇÚCAR

Nosso compromisso com o meio ambiente é tangível. Mantemos mais de 34 mil hectares de vegetação nativa conservados, e nosso Programa Águas da Guanabara já protege 245 nascentes há mais de 20 anos. (Foto preservação)

Nos comprometemos a ser Net Zero até 2035. Como parte dessa jornada, na última safra, tivemos a redução de 25% nas emissões de Gases de Efeito Estufa (GEE). Nossa excelência é validada pelo Selo Ouro do Programa GHG Protocol, somando-se a certificações em etanol, soja e nutrição animal. (Foto Net Zero)
Em campo, investimos na produção de 2,8 milhões de mudas pré-brotadas em nossa biofábrica do Centro Biotecnológico da Biomassa (CBB), um avanço que fortalece a resiliência agrícola, aumenta a produtividade e a eficácia no controle de pragas. (Foto CBB)

Levamos nossa energia às comunidades Nosso impacto positivo se estende às comunidades. Com o projeto Pensamos Verde, doamos mais de 80 mil mudas nativas na última safra, produzidas em nosso viveiro florestal, ampliando o desenvolvimento sustentável. (Foto Mudas de árvores)












A nossa energia de preservação vai além: através do Projeto Muda Mundo, estimulamos a economia circular e a consciência ambiental. O projeto envolve centenas de alunos, incentivando a reciclagem, reforçando que a sustentabilidade se constrói com a educação de base. Anualmente, investimos mais de R$ 1 milhão em educação, esporte, cultura e qualificação profissional por meio da Florescer Ação Social, impactando mais de 37 mil pessoas desde 2006 e promovendo a melhoria da qualidade de vida nas comunidades. (Foto Florescer)

Destacamos nosso sucesso no Programa +Possibilidades, que transforma vidas através da inclusão e capacitação de Pessoas com Deficiência (PcDs) em Gestão e Logística. Em parceria com o Senai-MT e Bioind MT, já envolvemos 113 PcDs, com a efetivação de 48 participantes em 2024, gerando oportunidades reais e transformadoras. (Imagem Mais Possibilidades)


Governança e Integridade
Nossa busca incessante por integridade nos impulsionou a aprimorar a governança corporativa. Realizamos investimentos significativos na atualização de políticas internas, aprimoramos o nosso Programa de Compliance e ampliamos os processos de due diligence para nossos parceiros, fornecedores e alta administração, assegurando a transparência e a segurança de toda a nossa cadeia de valor. (Imagem Funcionário UISA)

Somos energia, somos transformação
Somos uma empresa movida pela transformação e o resultado de quase 45 anos de visão e inovação. Unimo-nos à força do setor sucroenergético de Mato Grosso para entregar soluções essenciais ao mundo: de energia limpa aos alimentos. Nosso legado é construído hoje, no coração de Mato Grosso.














Sustentabilidade que transforma o presente e cultiva o futuro
Em um cenário em que eficiência e responsabilidade ambiental se tornam diferenciais estratégicos, a São José Agroindustrial, integrante do Grupo Cavalcanti Petribú, reafirma seu compromisso com um modelo de produção que une inovação, produtividade e respeito à natureza.
Localizada em Igarassu (PE), a companhia alia tradição e tecnologia para produzir açúcar, etanol e energia elétrica a partir da cana-de-açúcar — de forma responsável e comprometida com o desenvolvimento sustentável da região.
Na São José, tecnologia e sustentabilidade caminham lado a lado. Vivendo plenamente a era da Indústria 4.0, a empresa adota sistemas automatizados e soluções digitais que garantem mais precisão e eficiência em toda a cadeia produtiva. Aplicativos e ferramentas com inteligência artificial apoiam a tomada de decisão e o monitoramento em tempo real das operações agrícolas e industriais.
Um dos marcos desse avanço é o Centro de Operações Integrado (COI), implantado na última safra. O espaço reúne informações do campo e da indústria, permitindo acompanhar, minuto a minuto, o corte, o transporte e o processamento da cana, além da geração de energia. Essa integração promove maior agilidade, segurança operacional e redução de perdas — impulsionando a produtividade e reforçando o compromisso com uma gestão inteligente e sustentável.
A São José Agroindustrial mantém um portfólio robusto de certificações reconhecidas internacionalmente, como FSSC 22000, ISO 9001:2015, Bonsucro, RenovaBio e Selo Verde.
Esses selos atestam a busca constante pela excelência operacional, segurança alimentar, responsabilidade socioambiental e transparência nas práticas de governança.
Mais do que cumprir normas, a empresa entende que sustentabilidade é um valor que precisa ser vivido no dia a dia.
O compromisso com o meio ambiente e a sociedade se traduz em ações concretas de preservação, regeneração e uso responsável dos recursos naturais.
“Manejos adequados, conservação de espécies, preservação de matas e recursos hídricos são nossas bússolas. Mas nada disso seria possível sem as pessoas que fazem parte da nossa jornada”, destaca a companhia. “São elas que ajudam a construir não apenas um negócio sólido, mas um futuro possível.”



















A Construtora Fetz iniciou suas atividades na construção civil e firmou raízes em Videira no ano de 1983. Ganhou espaço no mercado através das grandes obras industriais e se tornou sinônimo de qualidade, agilidade e eficiência se tornando referência também no estado de Goiás.
Em 1999, a necessidade de utilizar técnicas que que começassem a trabalhar com concreto usinado e pré-moldados e assim melhoraram processos internos e também passaram a abastecer o mercado da construção civil em regiões de Santa Catarina e Goiás.
Contam com um extenso portfólio com mais de 500 projetos realizados com sucesso, atuando comdenciais e agroindustriais de grande porte e alto padrão.
Buscam constante aperfeiçoamento de equipamentos e maquinários, bem como treinamentos pa-
Acreditamos no crescimento conjunto. Onde de mãos dadas vamos juntos em busca de um mesmo objetivo.
O Grupo Fetz surgiu da vontade de fazer a diferença no mundo. Realizar sonhos e construir novas
A empresa que começou com cerca de três funcionários, hoje tem mais de 1000 colaboradores diretos e indiretos, que fazem parte de tudo que alcançamos, pois dedicam sua vida a realizar seu trabalho com dedicação e carinho.



A São José Agroindustrial está localizada em uma das regiões mais ricas em biodiversidade de Pernambuco — entre a Mata Atlântica e os manguezais da Mata Norte. Em suas áreas de influência direta, a empresa investe continuamente em projetos de recuperação e regeneração de matas ciliares, ampliando a presença de espécies da flora e da fauna locais.
A criação de microcorredores ecológicos é um dos destaques dessas iniciativas, promovendo a mobilidade e segurança da fauna silvestre. Essas ações integram o Plano de Biodiversidade da São José Agroindustrial, desenvolvido com base nos padrões da Bonsucro e voltado à conservação e manejo sustentável dos ecossistemas.
A região abriga uma impressionante variedade de espécies. Entre as aves, estão gaviões, jacus e pequenos pássaros. Nos mamíferos, destacam-se o macaco-prego-galego, o tamanduaí, a jaguatirica, o quati-de-cauda-anelada e a capivara. Répteis e anfíbios, como jiboias, teiús, rãs e pererecas, também fazem parte desse equilíbrio natural — além de peixes e crustáceos encontrados nos rios, riachos e manguezais, como tainhas, robalos, caranguejos e siris.
A flora local completa o cenário com espécies nativas da Mata Atlântica, como pau-brasil, jequitibá, ipê, cedro, bromélias e orquídeas, além de árvores e plantas com valor medicinal e alimentício, como a aroeira, a babosa, o cajueiro e a pitangueira. No total, a São José Agroindustrial mantém cerca de 10 mil hectares destinados à preservação ambiental — uma das maiores áreas contínuas de conservação da região.
Com base em seu Plano de Biodiversidade, a São José Agroindustrial adota medidas essenciais de conservação, como a proteção de habitats críticos, a restauração de ecossistemas degradados. Essas ações reforçam a convicção de que a biodiversidade é uma riqueza nacional que precisa ser cuidada com responsabilidade.
Na São José Agroindustrial, sustentabilidade não é apenas um conceito — é uma forma de fazer e pensar o negócio, garantindo que cada colheita seja também um investimento no futuro.

Em celebração ao Dia Mundial do Meio Ambiente, comemorado em 5 de junho, a Viralcool unidade Pitangueiras reforçou seu compromisso com a sustentabilidade por meio do projeto “Viralcool nas Escolas”, uma iniciativa de educação ambiental voltada a estudantes da rede pública municipal de Terra Roxa. As atividades foram conduzidas pelo Departamento de Meio Ambiente da empresa, que levou palestras educativas a algumas escolas do município.
“As três unidades da Viralcool promovem o plantio e doação de mudas para colaboradores, escolas
monitoramento por satélite e o apoio às brigadas de incêndio locais. Para a equipe da Viralcool, iniciativas como essa reforçam a importância de investir na formação de novas gerações mais conscientes e comprometidas com o meio ambiente. “Acreditamos que a conscientização começa pela educação, e é com orgulho que



A Viralcool deu mais um importante passo em sua jornada de valorização e reconhecimento interno. Em 2025, a unidade de Sertãozinho anunciou oficialmente as mudanças de funções entre seus colaboradores, um movimento que reforça o compromisso da empresa com o crescimento profissional e o desenvolvimento humano. Cada nova função representa não apenas uma mudança de cargo, mas também o reflexo do empenho, da dedicação e do engajamento diário dos colaboradores que contribuem para o sucesso da companhia.
Essas transições fazem parte de uma política contínua de incentivo ao aprendizado, ao aprimoramento de competências e à construção de







Apoio ao desenvolvimento profissional


colaboradores se destacaram pelos excelentes





Com quase 80 safras de história, a Zilor se destaca como uma das principais empresas do setor sucroenergético brasileiro. Fundada no interior de São Paulo, a companhia construiu uma trajetória marcada pela inovação, responsabilidade socioambiental e visão de futuro.
Presente em quatro unidades agroindustriais — Lençóis Paulista, Macatuba, Quatá e Lucélia — a Zilor possui capacidade de moagem de cerca de 14 milhões de toneladas por safra. Com mais de 4 mil colaboradores diretos, atende à crescente demanda por energia renovável e alimentos, contribuindo para um mundo em constante transformação. Além disso, é fundadora e acionista relevante da Copersucar, com 12% de participação na maior comercializadora global de açúcar e etanol, presente em mais de 70 países.
A Zilor integra os princípios de ESG (Environmental, Social and Governance) à sua governança corporativa e às decisões estratégicas. No pilar Ambiental, a empresa investe em tecnologias limpas, realiza
colheita 100% mecanizada e promove o uso eficiente dos recursos naturais. No Social, desenvolve programas voltados à educação, cultura, saúde, esporte e inclusão, com impacto direto nas comunidades onde atua. Já na Governança, adota práticas éticas, transparentes e responsáveis, com foco na integridade e na perenidade do negócio.
A Zilor também é pioneira no setor sucroenergético ao obter a declaração de conformidade com a prática recomendada ABNT PR 2030, norma lançada pela Associação Brasileira de Normas Técnicas que orienta empresas na estruturação e evolução de suas ações sustentáveis, alinhadas à Agenda 2030 da ONU.
Ao integrar inovação e eficiência às necessidades do planeta, a Zilor constrói um modelo de negócio cada vez mais consciente, resiliente e conectado aos desafios globais. Suas metas de sustentabilidade envolvem todos os níveis da organização — da alta liderança aos colaboradores — e refletem o compromisso da empresa com um mundo mais limpo, justo e preparado para as próximas gerações.
ATUAÇÃO EM TEMAS
IMPORTANTES E PRIORITÁRIOS
EM ACORDO COM
ODS DA ONU

Em diagnóstico ESG realizado na Companhia em 2021, a Zilor identificou nove temas “prioritários” e “importantes” que são reportados ao mercado, trimestralmente, de forma alternada.
Promoção do desenvolvimento socioeconômico
Gestão de carreiras e promoção das relações de trabalho
sustentáveis
Gestão da inovação
Estratégia ambiental
OBJETIVOS DE DESENVOLVIMENTO SUSTENTÁVEL
Respeito aos direitos humanos
Código de Conduta, prevenção da corrupção e de práticas anticompetitivas
ZILOR MAIS
SUSTENTÁVEL
Controle do solo e proteção dos recursos hídricos
Mudanças climáticas: adaptação e mitigação
Integração de fatores socioambientais na cadeia de valor
Em 2023, a empresa lançou o programa Zilor Mais
Sustentável 2030, que estabelece os compromissos e ambições para os próximos anos e tem seus progressos reportados ao mercado organizadas em cinco eixos estratégicos:
CLIMA E ENERGIA:
Plano de descarbonização & TCFD
ÁGUA E SOLO: Uso eficiente da água e conservação do solo.
PESSOAS E COMUNIDADES: Valorização da diversidade, equidade e inclusão.
INOVAÇÃO E CIRCULARIDADE: Fomento à economia circular e à inovação sustentável.
GOVERNANÇA E TRANSPARÊNCIA: Fortalecimento da cultura ética e da prestação de contas.
As metas sustentáveis da Zilor refletem um compromisso que vai além do discurso corporativo. Elas são desenhadas para envolver toda estrutura da empresa — da alta liderança aos colabora-
Temas ESG acompanhados e discutidos por comissão multidisciplinar periodicamente.
Temas ESG desdobrados em programas com metas de acordo com maturidade da Companhia.
Reporte bimestral à Diretoria em fórum ESG.
Inclusão de ESG nas metas do CEO e, consequentemente, nas metas Globais da Companhia.
Aderência de ESG à régua ABNT da PR 2030, com auditoria das práticas realizadas com definição de metas.
dores do campo — reforçando que a sustentabilidade é um valor compartilhado por todos.
COMPROMISSO GLOBAL E OLHAR PARA O FUTURO
A Zilor é signatária do Pacto Global da ONU, alinhando suas operações aos 10 Princípios Universais e contribuindo para os Objetivos de Desenvolvimento Sustentável (ODS). Essa adesão reforça o papel da empresa como agente de transformação e empresa cidadã, conectada aos desafios globais.
Com raízes firmes e visão voltada para o futuro, a Zilor segue determinada em sua missão de transformar a cana-de-açúcar em soluções que alimentam, energizam e impulsionam a transição energética global. Prestes a completar 80 anos, a companhia reafirma seu compromisso com o crescimento sustentável, com as comunidades onde está presente e com as próximas gerações — porque crescer com responsabilidade é o que move a Zilor.
Acesse o Relatório de Sustentabilidade www.zilor.com.br


Guia de Compras do sistema Bioenergético - 2025/2026
Abastecimento Comboio
SL Equipamentos 16 3946-3080
Abastecimento Equipamento
Ionics 48 3333-8666
Abastecimento Tanque
Bombas Andrade 17 3321-5811
Bozza 11 2179-9966
Gascom 16 2105-3622
Impacto Implementos 14 3623-9444
LDA Tanques 19 3838-9595
Mepel 54 3337-3700
Sage Oil Vac Brasil 11 2631-6343
SL Equipamentos 16 3946-3080
Sollus Agrícola 18 3421-1100
Acionamento Mecatrônico
SEW-EURODRIVE www.sew-eurodrive.com.br
Transtecno www.interpump.com.br/marcas/ transtecno 19 99203-7859 19 3437-2520
Aço carbono
Açotubo 11 2413-2000
NLMK 11 5694-2100 Sacchelli 11 2480-2299
SSAB 11 3303-0800
Uniweld 11 4035-8877
Vallourec 31 3328-2121
Aço em geral
Açobril 11 2207-6700
Jatinox 11 2060-0405
NLMK 11 5694-2100
São Joaquim 16 3810-1444
SSAB 11 3303-0800
Tubos Oliveira 11 3186-8000
Uniweld 11 4035-8877
Villares Metals 19 3303-8000
Aço Forjado
Villares Metals 19 3303-8000
Inox
Açofera 19 3451-9000
Açotubo 11 2413-2000
Águia Inox 54 3464-0191
Aperam 11 3818-1700
Arinox 11 2797-8000
Coppermetal 11 5547-8337
D&D Company 11 4072-4222
Elinox 11 2065-1400
Metalinox 11 2101-9000
NLMK 11 5694-2100
Uniweld 11 4035-8877
Villares Metals 19 3303-8000
Acoplast 31 2566-5900
Alvenius 11 4613-6266
Antares 54 3218-6800
Brastrela 11 3868-6100
Combel 17 3223-1282
Copabo 11 3741-6650
DPE 16 3627-3529
Geremia Redutores 54 2105-3211
John Crane 11 3371-2500
Lamiflex Couplings 11 4615-6300
Mademil 48 3436-6404
Martin Sprocket 19 3877-9400
Rexnord 51 3579-8080
Timken 11 5187-9200
Torkflex 16 3211-2181
Vedacert 16 3947-4732
Visão 11 2602-6533

Geo Agri 16 3965-8220
Herbicat 17 3524-9797
Hexagon Agriculture 48 4009-2704

Horus Aeronaves 48 3029-7600
Jacto 0800 772 2100

Novaterra 21 99341-7688
OMD do Brasil 16 3521-8433
Techsolo 14 3269-7233
Teejet 11 4612-0049
Trimble 19 3113-7000
Verion 11 2100-7400
Fácil System 16 3014-3270
Inbras 11 4056-6644
Mavi 11 3577-6200
MVL Máquinas 11 4596-9220

Alternador
Geraforte 31 3396-9694
Análise do solo e água
Athenas 16 3202-1872
SGS Brasil 11 3883-8800
Techsolo 14 3269-7233
Análise química e ambiental
Athenas 16 3202-1872
Mérieux NutriSciences 19 3417-4700
SGS Brasil 11 3883-8800
Andaime
0800 343 4021 21 99381-2770
Priner www.priner.com.br
Anel - bronze
Italbronze 11 2436-2900
Usina da Peça 16 3384-2121
Anticorrosão
Alvenius 11 4613-6266
Reframax 31 3029-8002
Rust Engenharia 11 3140-1500
Aplicação de insumos
Monitoramento
Hexagon Agriculture 48 4009-2704
Aplicação de produtos
Atendimento técnico

Biocane www.biocane.com.br
Área de vivência
Rodotrem 12 3687-1366
SL Equipamentos 16 3946-3080
Usingá 44 3266-2125
Armazenagem
Metalúrgica Rio Grande 16 3173-8100

Stolthaven www.stolthaven.com.br 13 3295-9000
Ultracargo 11 3177-6215 Vopak 13 3295-1000
Armazenagem de biomassa
ComBio 11 3030-0040
Dujua 47 3534-5000
E.M.G. 41 3641-7200 Zanella 41 2111-2300
de borracha
Anhembi Borrachas 11 2601-3311
Armo 16 3797-8900
Plant Rubber 16 3969-9777
Associação, Cooperativa e Entidade
Alcopar 44 3225-2929
Bioenergia Brasil 31 3228-5544
Bioind - MT 65 3642-2606
Biosul 67 3222-9252
Ceise-BR 16 3945-5422
CNA 61 2109-1400
CNI 11 3040-3860
19 3413-5066 19 3421-2080 19 99773-2125
Alfatek 17 3531-1075
Copercana www.copercana.com.br 16 3946-3300
Faesp e Senar www.faespsenar.com.br 11 3125-1333 11 3121-7233
Fiesp-SP 11 3549-4499
Orplana 16 99999-1610
Siamig 31 3228-5544
Sifaeg/Sifaçúcar - GO 62 3274-3133
Sindaçúcar - PI 86 3265-6905
Sindaçúcar-AL 82 2126-5500
Sindaçúcar-PE 81 2137-7622
Sindalcool 83 3513-1800
UDOP 18 2103-0528
Unem 65 4101-0060
Unica 11 3093-4949
ABB 0800 014 9111
AEI Assistech 16 3042-3871
AGTech Agrotecnologia 17 3305-5700
Alfa Laval 11 5188-6000
Andritz 41 2103-7601
Anton Paar 11 5906-9000
APS Componentes 11 2870-1000
Atma 16 2105-4945
Authomathika 16 3513-4000
Automatronic 47 3370-1403
Beckhoff 11 4126-3232
Bortolot 16 2105-0101
Bosch Rexroth 0800 704 5446
CNA 16 3965-1500
Compex 11 3900-9333
CS Compusoftware 18 3636-3800
Danfoss 11 2135-5400
Dimensional 19 3446-7400
Dismotor 19 3785-9000
DLG 16 3513 7400
Dynapar 11 3616-0150
Endress+Hauser 11 5033-4333
Fertron 16 3946-5899
Festo 11 5013-1600
Fourteam Engenheiros 22 2733-1441

Haver & Boecker www.haverbrasil.com.br
Helmut Mauell 11 2117-5353
Lander 18 3323-7613
Mectrol 14 4009-0507
Metaltex 11 5683-5700
Metso Outotec 15 2102-1700
Neles 15 2102-9600
Novus 51 3323-3600
Pepperl+Fuchs 11 4007-1448
Peu Eletricidade 19 3437-3030
Ram Automação 14 3604-8000
Salvi Casagrande 11 3327-0033
Saturno 51 3462-7415
Schmersal Brasil 15 3263-9800
Schneider 11 4501-3434
Servserth 16 3945-5964
0800 770 0496
SEW-EURODRIVE www.sew-eurodrive.com.br
SGS Brasil 11 3883-8800
Siembra Automação 19 3826-2599
Sindustrial 14 3366-5200
Smar 16 3946-3599
SMC Brasil 11 4082-0600
Solid Designer 11 97559-6518
SRS 16 3513-2500

Sucroanalitica www.sucroanalitica.com.br 16 3704-6161
TGM 16 2105-2600
TMSA 51 2131-3333
Unidata 31 3528-9900
Valmet 41 3341-4444
World Controles 19 3833-3131
Yaskawa 11 3585-1100
Yokogawa 11 3513-1300
Yon Elétrica 18 3823-1614
19 2141-2000 19 3879-9100 19 99679-5198
Embraer Agrícola 0800 772 8426
Lider Aviação 31 3490-4500
Avião agrícola
Comercialização
Aeroglobo 14 3814-3450
Embraer Agrícola 0800 772 8426
Balança e Sistema de pesagem
Balanças Jundiaí 11 4606-8400
Digi-Tron 41 3377-1577

Haver & Boecker www.haverbrasil.com.br
Mettler Toledo 11 4166-7400 Rinnert 47 3547-9100 Saturno 51 3462-7415

Sucroanalitica
Toledo do Brasil 0800 545 4122
Banco de microorganismos e leveduras Fermentec www.fermentec.com.br
Agrivalle Brasil 19 3885-8899 Koppert 0800 770 1919

Biogás
Paques 19 3429-0600
Sebigas-Cótica 51 3103-4442
Bomba e motobomba
Ajel Service 62 3295-3188
Anauger 11 4591-1661
Andritz 41 2103-7601
Atlas Copco 11 3478-8883
Bombas Beto 51 3562-3388

Bosch Rexroth 0800 704 5446
Bozza 11 2179-9966
Century do Brasil 11 2541-7145
Equipe Bombas 19 3417-4848
Fives Lille 16 3947-9029
Gascom 16 2105-3622
19 3682-7070 19 3682-7071
Germek www.germek.com.br
Helibombas 16 3333-5252
Hydac 11 4393-6600
Imbil 19 3843-9833
KSB 11 4596-8500
Lemasa 19 3936-8555
Linde Hydraulics 11 2281-7879
Mega Flux Bombas 11 5575-4160
Netzsch 47 3387-8222
ProMinent 11 4176-0722
Sulzer 11 4589-2000
Tectrol - Dínamo 43 3305-2500
Verion 11 2100-7400
WEG 47 3276-4000
Bombeiro Comboio
Gascom 16 2105-3622
Impacto Implementos 14 3623-9444
SL Equipamentos 16 3946-3080
Bombeiro Tanque

• Espectrômetros NIR
• Cromatografia iônica, líquida e gasosa
• Medidores de pH e condutividade

Motocana 19 3412-1234
SL Equipamentos 16 3946-3080
Cabine
Capota e Climatizador
Agroleite 17 3551-9090
Aral Cabines 54 3344-0022
Resfri Ar 54 3511-1111
Cabo de aço
Okubo 16 3514-9966
Siva 11 4646-4646
Cabo elétrico
Belden 11 4092-9000
Condumax 17 3279-3700
Cordeiro 11 4674-7400
• Balanças analíticas e de precisão
• Quimiometria e validação de curvas analíticas em NIR
• Manutenção preventiva e calibração em cromatografia gasosa e líquida
• Manutenção corretiva em placas eletrônicas
• Implementação de metodologia analítica em cromatografia








16 3704-6161 www.sucroanalitica.com.br


Dimensional 19 3446-7400
General Cable 11 3457-0300
IPCE 11 2065-1100
Nambei 11 5056-8900
Peu Eletricidade 19 3437-3030
Wirex Cable 11 2191-9400
Cal
3323-5010
Calpar 42 3232-8700
Caltec
Gecal 37 3323-5010
Geocal 11 4156-8999
Viter Agro 0800 008 4837
Caldeira
Andritz 41 2103-7601
Arauterm 51 3406-6979
Caldebras 19 3493-6530
Caldema 16 3946-2701
CBC 11 4431-3900
DanPower www.danpower.com.br 19 2106-6989
E-Machine 16 3511-9000
Engecass 47 3520-2500
Engetubo 19 3434-3433
Engevap 16 3513-8800
Equipalcool 16 3513-8000
Fimaco 47 3525-1000
Fives Lille 16 3947-9029
www.hpb.com.br 16 3513-4600 Interunion 16 2102-9200
Metalúrgica Rio Grande 16 3173-8100
Mitre Engenharia 16 3623-4021
Reverflux 18 3279-4257
Triniton 16 3511-2500
Valmet 41 3341-4444
Zanini Serviços 16 3518-9090
Caldema 16 3946-2701 E-Machine 16 3511-9000
HPB www.hpb.com.br 16 3513-4600
TKS 16 3942-2022
Zanini Serviços 16 3518-9090
Caldeiraria
Arxo 47 2104-6700
Citrotec 16 3303-9796
Equipalcool 16 3513-8000 FW 16 3041-6600
Grundfos 11 4393-5533
JEA 11 4547-6000
Krieger 47 3231-1311
Metalúrgica Rio Grande 16 3173-8100
Perenne 11 3022-6989
Reframax 31 3029-8002
SGS Brasil 11 3883-8800
TKS 16 3942-2022
Vemag 16 3511-1000
Zanini Serviços 16 3518-9090
ZBN 18 2102-9000
Caminhão e veículo
DAF 42 3122-8400
Ford 0800 703 3673
Foton 0800 799 2020
General Motors 11 4234-7700
Iveco 0800 702 3443
MAN Latin America 11 5582-5333
Mercedes-Benz 0800 970 9090
Scania 11 4344-7239
Toyota 0800 703 0260
Volkswagen 0800 770 1936
Volvo 41 3317-8111
XCMG 0800 770 8866
Carga e descarga Caminhão

Stolthaven www.stolthaven.com.br 13 3295-9000
Carregador de cana
Motocana 19 3412-1234
de fardos

Haver & Boecker www.haverbrasil.com.br 19 2141-2000 19 3879-9100 19 99679-5198
Motocana 19 3412-1234
Carreta - Piso móvel
BELTZ do Brasil 47 99755-7557

Carrocerias Bachiega www.carroceriasbachiega.com.br 19 3496-1555 19 99309-7571
Truckvan 11 2635-1133
Carreta - Pulverizadora
Agrimec 55 3222-7710 Coagril 35 3292-3931
Carreta - Vinhaça
Engcom 19 99645-1329
TMA 16 3969-4933
Unifibra 16 3663-8002
Carroceria
Reboque e semirreboque
BELTZ do Brasil 47 99755-7557
Usicamp 44 3264-8500
Usingá 44 3266-2125
Casquilho para moenda
Bronze
Italbronze 11 2436-2900
Cavalete automotivo
Linha pesada
Fortech Equipamentos 16 3333-5100
Centrífuga
Alfa Laval 11 5188-6000
Big Tecnologia 19 3414-3836
Brumazi 16 3946-8777
E-Machine 16 3511-9000
Fives Lille 16 3947-9029
Flottweg 19 3836-5300
GEA Westfalia 19 3725-3100
Mausa 19 3124-3030
Multisteel 19 3546-9878
Silver Weibull 16 3202-8614
Texas 82 2121-2000
Certificação
Cotecna 11 3383-1800
ESG Bannwart 17 98117-6490
Geoambiente 12 3878-6400
Lloyd’s Register – LRQA 11 3523-3940
SGS Brasil 11 3883-8800
Vanzolini 11 3145-3700
Chapa de aço
Açobril 11 2207-6700
Elinox 11 2065-1400
Intersteel


Haver & Boecker www.haverbrasil.com.br
Cilindro hidráulico Verion
Clarificante Alcolina

Colhedora
772 2100
891 4031
3456-5400

Colhedora
Estradeiro 16 3995-9899
John Deere 0800 891 4031
Lopes Tratores 16 3628-6622
Parker 12 4009-3500
Parkits 19 3421-8485
Plant Rubber 16 3969-9777
Reggiana Riduttori www.interpump.com.br/marcas/ reggiana 19 99203-7859 19 3437-2520
RLX 16 3101-1414
Serras Krüger 18 99801-3500
SL Equipamentos 16 3946-3080
Tracan 16 3456-5400
Tracbel Agro www.tracbelagro.com.br/ 16 3968-8080
Tratorag 19 3429-1444
Unimil 19 2105-0800
ABB 0800 014 9111
APS Componentes 11 2870-1000
E-Machine 16 3511-9000

Secmil www.secmil.com.br 12 3911-9496
Steck 11 2248-7000
Auteq 11 2107-1888
Herbicat 17 3524-9797
Hexagon Agriculture 48 4009-2704
Markanti 16 3941-3367
Solinftec www.solinftec.com 18 3622-2270

Brumazi 16 3946-8777
Citrotec 16 3303-9796
Texas 82 2121-2000
Construção industrial
CHB Locações 11 2909-1757
Construtec 17 3343-1123
Construtora Fetz www.fetz.com.br 49 3566-9800 64 98142-0010 Whats App
Engetrad 16 3821-5500
Fourteam Engenheiros 22 2733-1441
JBR Engenharia 19 3629-0411
Protendit 17 3214-7200
Reframax 31 3029-8002
SGS Brasil 11 3883-8800
Agronova 16 3951-1540
Azevedo Engenharia 19 3435-3300
Canaplan 19 3434-3099
Datagro 11 4133-3944
Engcom 19 99645-1329
Engsugar 14 3316-6260
ERG Engenharia 31 2138-4712
Agronova 16 3951-1540
Agrotools 11 3045-6636
Athenas 16 3202-1872
Cromai 11 2366-9406
ERG Engenharia 31 2138-4712
Geoambiente 12 3878-6400
Geopixel 12 3949-1991
MBF Agribusiness 16 3946-6474

BMA Ambiental www.bmaambiental.com.br 31 3649-1450 31 99781-6390
CLAM Meio Ambiente 31 3048-2000
Delta Ducon 11 3218-6666 Ecomax 11 4602-3900
ERG Engenharia 31 2138-4712
ESG Bannwart 17 98117-6490
Fourteam Engenheiros 22 2733-1441
Geoambiente 12 3878-6400
Geopixel 12 3949-1991
Horizonte Ambiental 19 3645-1830
Key Associados 11 4890-4111
KRAV 11 3661-9656
Novaterra 21 99341-7688
Powder 11 3218-6666
R. Roche & Associados 41 4125-1436
SGS Brasil 11 3883-8800
Fourteam Engenheiros 22 2733-1441
Geoambiente 12 3878-6400
Iprosucar 19 3402-1100
JBR Engenharia 19 3629-0411
MBF Agribusiness 16 3946-6474
Sucrana 16 3209-2727

Sucroanalitica www.sucroanalitica.com.br 16 3704-6161
Consultoria de comercialização de energia
Boven 11 2663-2910
Nova Energia 11 3124-4141
Replace Consultoria 11 5505-6637
Trader 81 3198-9850
Woodward 19 3708-4800
de negócios
Agile Solutions 11 5501-6555
Claritas Investimentos 11 2131-4900
Eba Consultoria 14 3269-7211
Engsugar 14 3316-6260
ERG Engenharia 31 2138-4712
Filius Venture 19 3324-3019
Geopixel 12 3949-1991
Globaldox 16 3913-5656
MBF Agribusiness 16 3946-6474
PWC 11 3674-2000

Sucroanalitica www.sucroanalitica.com.br
16 3704-6161
Bio Controle 19 3936-8450
BioControl 16 3945-0384
Lallemand Plant Care 34 3826-0400
de frequência
ABB 0800 014 9111
Vilage Marcas e Patentes 0800 703 9009
Wiabiliza 11 5584-8570
Consultoria industrial
Alkaiós 16 3945-5499
Azevedo Engenharia 19 3435-3300
Catena Engenharia 41 3336-1737
De Smet Empral 16 3209-1999
Engcom 19 99645-1329
Engsugar 14 3316-6260
ERG Engenharia 31 2138-4712
Fives Lille 16 3947-9029
JBR Engenharia 19 3629-0411
JRE Inspeções e Ensaios 19 3454-1292
MBF Agribusiness 16 3946-6474
PAC 11 4728-3120
Reframax 31 3029-8002

Sucroanalitica www.sucroanalitica.com.br
16 3704-6161
Container casa de bomba
19 3682-7070 19 3682-7071
Germek www.germek.com.br
SEW-EURODRIVE www.sew-eurodrive.com.br
0800 770 0496 Yaskawa 11 3585-1100
Coroa - bronze
Italbronze 11 2436-2900
Correia
Abrascort 41 2169-9999 CBV 11 4418-8080 Cobra 16 3603-3333
Comanbor 16 2133-5500
Continental ContiTech 0800 011 1572
Conveybelts 11 3538-8307
Copabo 11 3741-6650 Gates 11 5105-8100

Haver & Boecker www.haverbrasil.com.br 19 2141-2000 19 3879-9100 19 99679-5198
Molyplast 16 3963-9000
Suprir 16 2102-6500
Timken 11 5187-9200
Correia transportadora
Borpac 31 3311-2700
CICAB 19 3464-9292
Cofaco 19 3026-8888
Continental ContiTech 0800 011 1572
Conveybelts 11 3538-8307
Copabo 11 3741-6650
Correias Mercúrio 11 4588-6600

Haver & Boecker www.haverbrasil.com.br
19 2141-2000 19 3879-9100 19 99679-5198
IRBI 18 3631-5000
Techmaster 11 4414-1515
Valmet 41 3341-4444
Vulcatec 16 2133-8900
Peças e serviços
Borpac 31 3311-2700
Continental ContiTech 0800 011 1572

Link Steel www.linksteel.com.br 19 3493-9600
Martin Engineering 19 3709-7200
Corrente
Abrascort 41 2169-9999
Comanbor 16 2133-5500
FleckMulti 51 3038-6200
General Chains 19 3417-2800

Haver & Boecker www.haverbrasil.com.br 19 2141-2000 19 3879-9100 19 99679-5198
KMC 11 5548-4226

Link Steel www.linksteel.com.br 19 3493-9600
Okubo 16 3514-9966
Prolink 19 3423-4000
Rexnord 51 3579-8080
RUD 11 4723-4944
Siva 11 4646-4646
Timken 11 5187-9200
Cozedores
Brumazi 16 3946-8777
Fives Lille 16 3947-9029
Metalúrgica Rio Grande 16 3173-8100
Planusi 16 3513-9900
Decantador
Andritz 41 2103-7601
Brumazi 16 3946-8777
Fives Lille 16 3947-9029

Link Steel www.linksteel.com.br 19 3493-9600
Metalúrgica Rio Grande 16 3173-8100
Bozza 11 2179-9966
Gascom 16 2105-3622
LDA Tanques 19 3838-9595
Sollus Agrícola 18 3421-1100
Defensivo agrícola
Adama 43 3371-9000
Alta Defensivos 41 3071-9100
Ascenza 19 3709-3000
Basf 0800 019 2500
Bayer Cropscience 0800 011 5560
Bio Soja 16 3600-8688
Corteva 0800 772 2492
Espectro Insumos 67 99852-8874
FMC 19 3115-4400
HELM do Brasil 11 5185-4099
IHARA 15 3235-7700
Nufarm 0800 725 4011
Polim-Agri 43 3024-1008
Sipcam Nichino 34 3319-5550
Sumitomo Chem 11 3287-9529
Syngenta 11 5643-3322
UPL do Brasil 19 3794-5600
Brumazi 16 3946-8777
Dedini 19 3403-3222
ESCO 31 3539-1200
Eutectic 16 3521-2350
Fernavan 16 3945-5231
Fives Lille 16 3947-9029
IRBI 18 3631-5000
Magíster 16 3513-7200
Metalúrgica Rio Grande 16 3173-8100
Moreno 16 3946-5000
Solid Designer 11 97559-6518
Brumazi 16 3946-8777
Dedini 19 3403-3222
E-Machine 16 3511-9000
Fives Lille 16 3947-9029

Link Steel www.linksteel.com.br
Drone
19 3493-9600
AGTech Agrotecnologia 17 3305-5700
Geo Agri 16 3965-8220
Horus Aeronaves 48 3029-7600
XMobots 16 99422-3022
Eixo
ADR Eixos 16 3965-3946
Estradeiro 16 3995-9899
Fazanaro 19 3493-9430
General Chains 19 3417-2800

Link Steel www.linksteel.com.br
19 3493-9600
Prolink 19 3423-4000 Tec Tor 11 4428-2888
Eletromagnético Equipamentos
Alphamag 19 3324-5094
CHB Locações 11 2909-1757
Inbras 11 4056-6644
Oximag 11 4435-3778
Elevador
Brumazi 16 3946-8777
HMBL 19 3444-7763

Link Steel www.linksteel.com.br
Magnus Hidráulica 11 2422-7944
19 3493-9600
Martin Sprocket 19 3877-9400 Mavi 11 3577-6200
Solid Designer 11 97559-6518
Techmaster 11 4414-1515

Haver & Boecker www.haverbrasil.com.br 19 2141-2000 19 3879-9100 19 99679-5198
Neoplastic 11 4443-1000 SR Embalagens 17 3321-2222

Sucroanalitica www.sucroanalitica.com.br 16 3704-6161
Empilhadeira
Auxter 11 3602-6000
BMC - Hyundai 11 99687-8218
Techmaster 11 4414-1515
Terex 0800 031 0100
Yale 11 4134-4700
Energia Comercialização
Boven 11 2663-2910
Cemig 0800 721 0116
CPFL Brasil 19 3795-3900
Diferencial 21 2169-5900
Energisa Comercializadora 21 2122-6949
NC Energia 21 3235-8900
Nova Energia 11 3124-4141
Tractebel 48 3221-7000
Trader 81 3198-9850
Energia Controle e gerenciamento
ABB 0800 014 9111
Geraforte 31 3396-9694
Motrice SE 81 2122-2300
Smar 16 3946-3599

Sucroanalitica www.sucroanalitica.com.br 16 3704-6161
Yokogawa 11 3513-1300
Energia Equipamentos
Bambozzi 16 3383-3800
Dedini 19 3403-3222
Elétrica PJ 11 3649-9800
Geraforte 31 3396-9694
Metalúrgica Rio Grande 16 3173-8100
Motrice SE 81 2122-2300
SEL 19 3515-2000
Sindustrial 14 3366-5200
Siner 11 4181-6999
Stemac 0800 723 3800
Energia Gerador
ABB 0800 014 9111
Aggreko 0800 437 2367
Ajel Service 62 3295-3188
Bambozzi 16 3383-3800
Cummins 0800 286 6467
E-Machine 16 3511-9000
FPT TRACAN 16 3456-5400
Geraforte 31 3396-9694
Germek www.germek.com.br 19 3682-7070 19 3682-7071
Interunion 16 2102-9200
Metalock 13 3226-4686
Motrice SE 81 2122-2300
Rodotrem 12 3687-1366
Solaris 11 2173-8685
Sotreq 0800 084 8585
Stemac 0800 723 3800
Diferencial 21 2169-5900
Engevix 11 2106-0100
Geraforte 31 3396-9694
Innovatech Gestão 19 3324-3019
Motrice SE 81 2122-2300
Nova Energia 11 3124-4141
Replace Consultoria 11 5505-6637
SGS Brasil 11 3883-8800
Sucrana 16 3209-2727
TMSA 51 2131-3333
Energia Recuperação
Atlas Copco 11 3478-8883
Bonfiglioli 11 4344-2323
Clyde Bergemann 19 3811-8080
Aggreko 0800 437 2367
Atlas Copco 11 3478-8883
Rodotrem 12 3687-1366
Solaris 11 2173-8685
Enfardadeira Fio
Okubo 16 3514-9966
Tama Brasil 75 4009-2000
AEI Assistech 16 3042-3871
Authomathika 16 3513-4000
Azevedo Engenharia 19 3435-3300
Bortolot 16 2105-0101
Bosch Engenharia 19 3301-8101
Citrotec 16 3303-9796
De Smet Empral 16 3209-1999
DSJ Energia 16 3947-9830
Engcom 19 99645-1329
Engenovo 21 2223-0899
Engetrad 16 3821-5500
Engsugar 14 3316-6260
ETEC Engenharia 34 3334-6400
19 2105-6100 19 2105-6101
Fermentec www.fermentec.com.br
Fives Lille 16 3947-9029
Fourteam Engenheiros 22 2733-1441
Iprosucar 19 3402-1100
Irriga Engenharia 62 3088-3881
JBR Engenharia 19 3629-0411
Ram Automação 14 3604-8000
Reunion 11 4156-6688
SGS Brasil 11 3883-8800
Smar 16 3946-3599
Solid Designer 11 97559-6518
Sucrana 16 3209-2727
Welding 16 3513-8600
Engrenagem
ADDN 16 3946-3826
Fazanaro 19 3493-9430
General Chains 19 3417-2800

Link Steel www.linksteel.com.br
19 3493-9600
Martin Sprocket 19 3877-9400
Prolink 19 3423-4000
Reggiana Riduttori www.interpump.com.br/marcas/ reggiana 19 99203-7859 19 3437-2520
SEW-EURODRIVE www.sew-eurodrive.com.br
Transtecno www.interpump.com.br/marcas/ transtecno 19 99203-7859 19 3437-2520
Zanini Renk 16 3518-9000
Zanini Serviços 16 3518-9090

Stolthaven www.stolthaven.com.br 13 3295-9000

Biocane www.biocane.com.br
19 3413-5066 19 3421-2080 19 99773-2125
Centerquimica 18 3631-1313 DND Química 16 3943-5283
Fermentec www.fermentec.com.br 19 2105-6100 19 2105-6101
IFF 11 3533-5000
Lallemand 11 94393-3799
LNF 54 2521-3124
Novozymes 41 3641-1000
Prozyn 11 3732-0000
Aluga Solda 11 4617-9696
Ansell 11 3356-3100
Armo 16 3797-8900
Bracol 14 3533-2200
Dimensional 19 3446-7400
Gigatudo by Distrinox EPI 16 3969-8080
Iris Safety 11 2613-7506
Martineli Agrícola 16 2105-8000
Nexus 16 3945-5572
Unibrasil 17 3421-1780
Uniweld 11 4035-8877
X-5 11 3586-8700
Auxter 11 3602-6000
BMC - Hyundai 11 99687-8218
E-Machine 16 3511-9000
Komatsu 11 4745-7000
Sotreq 0800 084 8585
Tracbel 0800 200 1000
Volvo 41 3317-8111
XCMG 0800 770 8866
Base

Antractor 19 3129-5150
Brumazi 16 3946-8777
Fragmaq 11 4056-8057
General Chains 19 3417-2800
HMBL 19 3444-7763
IRBI 18 3631-5000

Link Steel www.linksteel.com.br
Metalúrgica Rio Grande 16 3173-8100 Moreno 16 3946-5000
Prolink 19 3423-4000
Rexnord 51 3579-8080
Siembra Automação 19 3826-2599
Solid Designer 11 97559-6518
Techmaster 11 4414-1515
Tecnometal 31 2122-2724
Fourteam Engenheiros 22 2733-1441
JEA 11 4547-6000
Reframax 31 3029-8002
celulósico Processos
Andritz 41 2103-7601
Clariant 11 5683-7233
Fourteam Engenheiros 22 2733-1441
Novozymes 41 3641-1000
Valmet 41 3341-4444
Evaporação Equipamento
Andritz 41 2103-7601
Brumazi 16 3946-8777
Citrotec 16 3303-9796
Dedini 19 3403-3222
E-Machine 16 3511-9000
Fives Lille 16 3947-9029
JW 16 3513-2000

Link Steel www.linksteel.com.br
19 3493-9600
Metalúrgica Rio Grande 16 3173-8100
NG Metalúrgica 19 3429-7272
Planusi 16 3513-9900
Solid Designer 11 97559-6518
TJA 16 3953-9696
Fábrica de açúcar Manuseio e estocagem
Brumazi 16 3946-8777
Fives Lille 16 3947-9029
Fourteam Engenheiros 22 2733-1441

Link Steel www.linksteel.com.br
19 3493-9600
Metalúrgica Rio Grande 16 3173-8100
Faca
Açokorte 11 4013-8080
Duraface 19 3547-3539
Eutectic 16 3521-2350
Magíster 16 3513-7200
Fermentação Equipamentos
Brumazi 16 3946-8777
Dedini 19 3403-3222
JW 16 3513-2000

Link Steel www.linksteel.com.br
19 3493-9600
Metalúrgica Rio Grande 16 3173-8100

Sucroanalitica www.sucroanalitica.com.br 16 3704-6161
Fermentação Produtos
Agrária 16 3690-2200
Alcolina 16 3951-5080

Biocane www.biocane.com.br 19 3413-5066 19 3421-2080 19 99773-2125
Centerquimica 18 3631-1313
Fermentec www.fermentec.com.br
Grupo ENG www.grupoeng.ind.br
OniBras 16 3969-4957
Química Real 31 3057-2000
Solenis 11 3089-9225
Ferramenta elétrica
Aluga Solda 11 4617-9696
Fuzil 19 3641-5900
Gigatudo by Distrinox EPI 16 3969-8080
Rolimac 16 3979-7009
Ferramenta manual
Apex Tool Group 15 3238-3925
Belenus 19 3826-7000 Especifer 19 3936-9797
Fuzil 19 3641-5900
Gigatudo by Distrinox EPI 16 3969-8080
Rolimac 16 3979-7009
Fertilizante e corretivo
Adufértil 11 4858-5939
Agrária 16 3690-2200
Agrobiológica 19 3572-1918
Agronelli 0800 940 0013
Agroplanta 16 3660-6500
Agrowiser 11 4044-4300
Allplant 17 3323-8393
Axihum 16 99737-0588
Bio Soja 16 3600-8688
41 3603-8000 41 3603-8001
Caltec www.caltec.com.br
CMOC 13 3362-7000
Compass Minerals 11 3016-9600
Compo 48 3722-9500 67 99852-8874

FASSAGRO
www.fassagro.com.br 16 3946-9300 16 3511-1400
Fertec 17 3324-1112
Follyfertil 16 2138-8777
Gecal 37 3323-5010
Green Has 11 4561-6292
Grupo Fertipar 41 3026-9009
Heringer 19 3322-2200
Hinove Fertilizantes Especiais 16 3322-7481
ICL Brasil 11 2155-4500
Kimberlit 17 3279-1500
MICROGEO 19 4003-5122
Microquimica Tradecorp 19 2137-8100
Mosaic 11 4950-2600
Nutrien 11 3047-1140
Nutrigesso 16 3772-2100
Nutrivale 14 3269-7233
Plant Defender 19 2114-2800
Redi Fertilizantes 43 3398-1719
Santa Clara 16 3620-3320
Sementes Piraí 19 2106-0260
Supraphos 16 3772-2100
Timac 51 3382-8700
Ubyfol 34 3319-9500
UPL do Brasil 19 3794-5600
Valagro 11 5054-4222
Vale 13 3369-9000
Viter Agro 0800 008 4837
YARA 51 3230-1300
Yoorin Fertilizantes 35 3729-1840
Construtec 17 3343-1123
Irriga Engenharia 62 3088-3881
ProFibra 16 3343-1788
Delta Ducon 11 3218-6666
Laffi 11 4438-4040
Mecat 62 3503-1155
Powder 11 3218-6666
Açofiltro 15 3225-3005
Acquasys 11 3628-1982
ACT 11 2893-9670
AERO Tecnologia do Ar 11 2152-7100
Astefa 16 3942 5511
Astral Ambiental 41 3346-2200
Bariontec 16 3368-1949
Bernauer 11 2666-3909
Comanbor 16 2133-5500
Cummins 0800 286 6467
D&D Company 11 4072-4222
Dedini 19 3403-3222
Delta Ducon 11 3218-6666
Duppai 16 3771-3777
E-Machine 16 3511-9000
Equilíbrio 16 3946-2433

Grupo Veco 19 3787-3700 Hidrara www.hidrara.com.br 16 3508-1300
Hidro-Ambiental 19 3572-9999
Hydac 11 4393-6600
Imporcate 0800 721 3811
John Crane 11 3371-2500
Jotaflex 11 3308-6600
Laffi 11 4438-4040
Magnus Hidráulica 11 2422-7944
MCFIL 19 3826-8398
Mecat 62 3503-1155
Neolíder 11 4393-6000
Parker 12 4009-3500
Petroserv 11 2940-1955
Powder 11 3218-6666
Prominas 16 3375-9119
ProMinent 11 4176-0722
Reverflux 18 3279-4257
Stauff 11 4772-7200
Tecnoval 16 3944-9900
TMSA 51 2131-3333
VLC 19 3812-9119
Freio industrial
Caldema 16 3946-2701
0800 770 0496
Fourteam Engenheiros 22 2733-1441
Rentank Macrogalpões 11 4138-9266
Tópico 0800 120 1200
Gás natural
GasBrasiliano 0800 773 6099
Anhembi Borrachas 11 2601-3311
Armo 16 3797-8900
Bermo 47 2123-4444
CBV 11 4418-8080
Chesterton 11 3382-4900
Cofaco 19 3026-8888
John Crane 11 3371-2500
Luciane 11 4414-1700
Parkits 19 3421-8485
Real 19 3444-6737
Teadit 21 2132-2500
SEW-EURODRIVE
www.sew-eurodrive.com.br
Tec Tor 11 4428-2888
Vulkan do Brasil 11 4894-7300
Fundição
Euroair 54 3227-2753
Ferrusi 16 3946-4766
Fundição Água Vermelha 16 3513-2300
Greenbrier 12 2122-1400
Magíster 16 3513-7200
Metalcury 16 3969-8100
Metalúrgica Pérola 43 3532-3411
Moreno 16 3946-5000
Uniweld 11 4035-8877
ZBN 18 2102-9000
Fundição - bronze
Italbronze 11 2436-2900
Maccaferri 11 4525-5000
Neoplastic 11 4443-1000
e topografia
Agrotools 11 3045-6636
Altave 12 3913-5900
Engesat 41 3023-1617
ERG Engenharia 31 2138-4712
Geoambiente 12 3878-6400
Geopixel 12 3949-1991
Grupo WZ 19 3569-5100
Horus Aeronaves 48 3029-7600
Imagem - Esri 12 3946-8966
OPT GIS 12 3302-4443
Sigma Sensors 12 3933-3291
Soft Mapping 41 3276-2004
Trimble 19 3113-7000
19 3881-8644 19 99913-4032
Chemlub
www.chemlub.com.br
ITW Chemical 11 4785-2630
Klüber 11 4166-9000
Rolimac 16 3979-7009
Schaeffler 15 3335-1500
Guincho
Brumazi 16 3946-8777
E-Machine 16 3511-9000
Feldermann Forest 48 98419-2428
Terex 0800 031 0100
Tracbel 0800 200 1000
Bauma 15 3242-8080
Êxito 81 3464-1111
Motocana 19 3412-1234
TKA Guindastes 54 3202-3000
Usicamp 44 3264-8500
XCMG 0800 770 8866
Lander 18 3323-7613
Magnus Hidráulica 11 2422-7944
Salvi Casagrande 11 3327-0033
Tectrol - Dínamo 43 3305-2500
Unimil 19 2105-0800
Geoambiente 12 3878-6400
Geopixel 12 3949-1991
Novaterra 21 99341-7688
OPT GIS 12 3302-4443
Agrimec 55 3222-7710
Agromatão 16 3382-7192
Almeida 16 3348-9000
Antoniosi 16 3384-8000
Baldan 16 3221-6575
Berma 19 99203-7859
BM Dumont 16 3944-1397
Bouwman 42 3234-1108
Budny 48 3432-0096
Civemasa 16 3382-8282
Coagril 35 3292-3931
DMB 16 3946-1800
Dria 16 3969-4933
Duraface 19 3547-3539
Eco Agro 17 3567-9600
GTS do Brasil 49 3241-7100
Ikeda 14 3408-1000
John Deere 0800 891 4031
Kuhn do Brasil 54 3316-6200
LS Mtron 47 3085-8101
Mecmaq 19 3417-4090
Mepel 54 3337-3700

Motocana 19 3412-1234
Pinheiro 19 3843-9250
Sollus Agrícola 18 3421-1100
Terraverde 19 3674-0000
Usicamp 44 3264-8500
Usingá 44 3266-2125
AB Rodofort 19 3770-2200
BELTZ do Brasil 47 99755-7557
Carmetal 54 3329 8500

Carrocerias Bachiega www.carroceriasbachiega.com.br
19 3496-1555 19 99309-7571
Facchini 17 3426-2000
Impacto Implementos 14 3623-9444
LDA Tanques 19 3838-9595
Mepel 54 3337-3700
Randon Implementos 54 3239-2000
Rodotrem 12 3687-1366

Sergomel www.sergomel.com.br 16 3513-2600
Truckvan 11 2635-1133
Unifibra 16 3663-8002
Usicamp 44 3264-8500
Inspeção industrial
Açúcar e etanol
Azevedo Engenharia 19 3435-3300
DSJ Energia 16 3947-9830
Engcom 19 99645-1329
JRE Inspeções e Ensaios 19 3454-1292
JW 16 3513-2000
Perticarari 16 3235-9837
Priner www.priner.com.br 0800 343 4021 21 99381-2770
SD Engenharia 16 3524-4801
SGS Brasil 11 3883-8800
TransmiService 16 3946-4600
Welding 16 3513-8600
Instalação industrial
Açúcar e etanol
AEI Assistech 16 3042-3871
Authomathika 16 3513-4000
Dedini 19 3403-3222
Ecomax 11 4602-3900
Fives Lille 16 3947-9029
JBR Engenharia 19 3629-0411
Metalúrgica Rio Grande 16 3173-8100
Planusi 16 3513-9900
Instrumento de medição
Contech 11 5035-0920
Endress+Hauser 11 5033-4333
Marrari 41 3332-9393
Metroval 19 2127-9400
Nivetec 11 2627-6600
Peu Eletricidade 19 3437-3030
ProMinent 11 4176-0722
Salvi Casagrande 11 3327-0033
Sigma Sensors 12 3933-3291
World Controles 19 3833-3131
Inversor de frequência
Bonfiglioli 11 4344-2323
Metaltex 11 5683-5700
Nord Drivesystems 11 2402-8855
Schmersal Brasil 15 3263-9800
Tectrol - Dínamo 43 3305-2500
Yaskawa 11 3585-1100
Inversor solar
ABB
0800 014 9111
Fronius 11 3563-3800
Schneider 11 4501-3434
WEG 47 3276-4000
Irrigação Equipamentos
Asperbras 18 3654-7000
Bauer 19 3634-1212
Bermad 19 3573-8888
Engcom 19 99645-1329
Gascom 16 2105-3622
19 3682-7070
Germek www.germek.com.br
19 3682-7071
Hidro Sistemas 11 3744-4467
Irrigabrás 11 2842-6464 Krebsfer 19 3119-4000 Lindsay 19 3814-1100


Além


Martin Engineering 19 3709-7200
OniBras 16 3969-4957
Reframax 31 3029-8002
Logística e transporte

Agicargo www.agicargobr.com 16 3041-5787
Aguetoni Transportes 17 3330-2455 Ambipar 11 3429-5000

Expresso Nepomuceno www.expressonepomuceno.com.br 35 3694-9946 35 99104-8480
Gafor 11 2107-3100
JSL 11 2377-7000
Logum 21 2517-5200
Quadrante Logistica 16 3521-8420
Raça 18 2104-5555
Rumo ALL 0800 701 2255

Stolthaven www.stolthaven.com.br 13 3295-9000
Transespecialista 16 2105-7870
Transvalco 16 3954-8400
Lubrificante e Aditivo
Agecom 11 2149-8922
Armo 16 3797-8900
Bardahl 11 4898-8600
BR Petrobras 0800 728 9001
Castrol 0800 704 0720
Chemlub www.chemlub.com.br 19 3881-8644 19 99913-4032
Chesterton 11 3382-4900
Cobra 16 3603-3333
Comanbor 16 2133-5500
Condat 11 4012-3100
Coremal 11 4615-8142 Fuchs 11 4789-2311
Hennings 47 3036-5555
Homy Química www.homyquimica.com.br 16 3690-1000
Iconic 0800 704 2230
Ipiranga 0800 025 3805
ITW Chemical 11 4785-2630
Klüber 11 4166-9000 Moove 0800 644 1562
Petronas 0800 883 3200 Platinum 11 3665-4000 Sil 11 4433-3753
Bombas Andrade 17 3321-5811
Bozza 11 2179-9966
Gascom 16 2105-3622
Impacto Implementos 14 3623-9444
LDA Tanques 19 3838-9595
Sage Oil Vac Brasil 11 2631-6343
A.T.I. Brasil 41 3302-3400
Brastrela 11 3868-6100
Cobra 16 3603-3333
CS Turbinas 16 3511-6000
Fazanaro 19 3493-9430
General Chains 19 3417-2800
John Crane 11 3371-2500

Link Steel www.linksteel.com.br 19 3493-9600
A.T.I. Brasil 41 3302-3400
Brastrela 11 3868-6100
Cobra 16 3603-3333
CS Turbinas 16 3511-6000
Fazanaro 19 3493-9430
General Chains 19 3417-2800
John Crane 11 3371-2500
Mancal - bronze
Italbronze 11 2436-2900
Usina da Peça 16 3384-2121
Mangueira
Alvenius 11 4613-6266
Armo 16 3797-8900
Borpac 31 3311-2700
Comanbor 16 2133-5500
Continental ContiTech 0800 011 1572
Contuflex 11 3070-0300
Copabo 11 3741-6650
Gates 11 5105-8100
Bambozzi 16 3383-3800
Big Tecnologia 19 3414-3836
Catena Engenharia 41 3336-1737
CPFL Serviços 19 3795-3900
Engetubo 19 3434-3433
Fertron 16 3946-5899
Fives Lille 16 3947-9029

Haver & Boecker www.haverbrasil.com.br 19 2141-2000 19 3879-9100 19 99679-5198
ICP Latin América 11 4496-4320

Intacta www.intactarolamentos.com.br 14 3641-0914 11 98272-0914
Intecnial 54 2107-8000

Hennings 47 3036-5555
Hidrara www.hidrara.com.br 16 3508-1300
Magnus Hidráulica 11 2422-7944
Parker 12 4009-3500
Petroserv 11 2940-1955
Specma 41 3669-6569
Tetralon 11 4081-7000
Manutenção elétrica
Metalock 13 3226-4686
Obo Bettermann 15 3335-1382
SGS Brasil 11 3883-8800
Manutenção hidráulica
Lander 18 3323-7613
Manutenção industrial
AEI Assistech 16 3042-3871
Ajel Service 62 3295-3188
Andritz 41 2103-7601
Authomathika 16 3513-4000
Irmãos Passaúra 41 2141-7000
Magíster 16 3513-7200
Martin Engineering 19 3709-7200
0800 343 4021 21 99381-2770
Priner www.priner.com.br
Reframax 31 3029-8002
SGS Brasil 11 3883-8800
Smar 16 3946-3599

Sucroanalitica www.sucroanalitica.com.br 16 3704-6161
Sulcromo 51 2112-2600
Tec Tor 11 4428-2888 Texas 82 2121-2000
TransmiService 16 3946-4600
Valmet 41 3341-4444
Vulcatec 16 2133-8900
Welding 16 3513-8600
World Controles 19 3833-3131
ZBN 18 2102-9000
Manutenção preditiva e preventiva
Ajel Service 62 3295-3188
Andritz 41 2103-7601
Authomathika 16 3513-4000
Azevedo Engenharia 19 3435-3300
Fives Lille 16 3947-9029

Haver & Boecker www.haverbrasil.com.br 19 2141-2000 19 3879-9100 19 99679-5198
JRE Inspeções e Ensaios 19 3454-1292
M&M Labtest 16 3434-4666
Reggiana Riduttori www.interpump.com.br/marcas/ reggiana 19 99203-7859 19 3437-2520
0800 770 0496
SEW-EURODRIVE www.sew-eurodrive.com.br
SGS Brasil 11 3883-8800

Sucroanalitica www.sucroanalitica.com.br 16 3704-6161
Techoleo 14 3269-7319
Tecnoval 16 3944-9900
Transtecno www.interpump.com.br/marcas/ transtecno 19 99203-7859 19 3437-2520
Zanini Renk 16 3518-9000
Manutenção
Transformador de potência
Ajel Service 62 3295-3188
Bambozzi 16 3383-3800
SGS Brasil 11 3883-8800
Manutenção Vibração
Ajel Service 62 3295-3188
SEW-EURODRIVE www.sew-eurodrive.com.br
Máquina agrícola
Agrimec 55 3222-7710
Antoniosi 16 3384-8000
John Deere 0800 891 4031
Terraverde 19 3674-0000
Máquina agrícola Locação
Armac 11 3081-5860
FCN 19 98159-0609
Ouro Verde 41 3239-7000
Rodobens 11 2139-3000
Material rodante
Antractor 19 3129-5150
Imporcate 0800 721 3811 ITM 11 4417-7772 ITR 11 3340-7555
Lopes Tratores 16 3628-6622
Maktractor 62 3596-2624
Medição
Equipamentos
Contech 11 5035-0920
Cotergavi 11 3673-5020
Endress+Hauser 11 5033-4333
Magnus Hidráulica 11 2422-7944
Metroval 19 2127-9400
Mettler Toledo 11 4166-7400
Nivetec 11 2627-6600
Pd Instrumentos 11 4016-4600
Presys 11 3056-1900
Rezenflex 19 3412-1144
Salvi Casagrande 11 3327-0033
Sigma Sensors 12 3933-3291
Smar 16 3946-3599 Sucroanalitica www.sucroanalitica.com.br 16 3704-6161

Mavi 11 3577-6200 MVL Máquinas

Anton Paar 11 5906-9000
Contech 11 5035-0920
Cotergavi 11 3673-5020
Dwyler 11 2682-6633
Endress+Hauser 11 5033-4333
Metroval 19 2127-9400
Nivetec 11 2627-6600
Petroserv 11 2940-1955

Verion 11 2100-7400
Willtec 11 4035-7500
World Controles 19 3833-3131

Moenda Equipamento Brumazi 16 3946-8777 Dedini 19 3403-3222
Dourados 16 3513-8500 E-Machine 16 3511-9000
Eutectic 16 3521-2350
Fives Lille 16 3947-9029
Magíster 16 3513-7200 Moreno 16 3946-5000
Simisa 16 2105-1200
Tecnometal 31 2122-2724
Thermic 14 3283-8283
Turbimoendas 19 3425-1900
Villares Metals 19 3303-8000
ZBN 18 2102-9000
Monitoramento Equipamentos
AGR 65 3023-0083
Altave 12 3913-5900
Creare Sistemas 51 3094-9090

Haver & Boecker www.haverbrasil.com.br 19 2141-2000 19 3879-9100 19 99679-5198
Horus Aeronaves 48 3029-7600
Presys 11 3056-1900

Secmil www.secmil.com.br

Sucroanalitica www.sucroanalitica.com.br
12 3911-9496
16 3704-6161
TMSA 51 2131-3333
Azevedo Engenharia 19 3435-3300
Citrotec 16 3303-9796
Engcom 19 99645-1329
Engevix 11 2106-0100
Irmãos Passaúra 41 2141-7000
Mafer 62 3353-7386
0800 343 4021 21 99381-2770
Priner www.priner.com.br
Reframax 31 3029-8002
Reverflux 18 3279-4257
SGS Brasil 11 3883-8800
Sindustrial 14 3366-5200
ZBN 18 2102-9000
Motoniveladora
Êxito 81 3464-1111
Sotreq 0800 084 8585
Volvo 41 3317-8111
XCMG 0800 770 8866
Motor
ABB
0800 014 9111
Acoplast 31 2566-5900
Ajel Service 62 3295-3188
Bonfiglioli 11 4344-2323
Branco 41 3211-4040
Cummins 0800 286 6467
Dimensional 19 3446-7400
Dismotor 19 3785-9000
E-Machine 16 3511-9000
FPT TRACAN 16 3456-5400
Imporcate 0800 721 3811
Interunion 16 2102-9200
Jotaflex 11 3308-6600
Linde Hydraulics 11 2281-7879
Magnus Hidráulica 11 2422-7944
MVL Máquinas 11 4596-9220
MWM 11 3882-3200
Nord Drivesystems 11 2402-8855
0800 770 0496
SEW-EURODRIVE www.sew-eurodrive.com.br
Stemac 0800 723 3800
Tectrol - Dínamo 43 3305-2500
19 99203-7859 19 3437-2520
Transtecno www.interpump.com.br/marcas/ transtecno
WEG 47 3276-4000
Movimentação industrial
Auxter 11 3602-6000
SGS Brasil 11 3883-8800
Techmaster 11 4414-1515
TMSA 51 2131-3333
Muda de cana
Explante 19 99707-1587
SBW do Brasil 19 3902-4041
Muda de eucalipto
Agriflora 16 3322-6488

Angico's www.mudasangicos.com.br 14 3267-2204
Bela Vista 35 3832-1132
Bortoli 43 99979-0240
Brotale Florestal 67 99963-1983
Camará 16 3343-1668
Dacko 54 3375-1250
Du Campo 27 3273-1010
Duffatto 47 3654-0944
Emflora 27 3313-9000
Flora Sinop 66 3531-6691
Golden Tree 42 3624-1096
Multifloresta 14 3731-2556
Planflora 49 3442-5433
SBW do Brasil 19 3902-4041
Tecnoplanta 51 3482-1343
Vasconcelos 16 3242-2975
Viveiro Pavão 16 3721-6977
Viveiro Schorr Flora 42 3522-8716
Viveiro Taquara 77 3611-0618
Evonik Degussa 11 3146-4100
Hydroplan 11 3322-7000
Polim-Agri 43 3024-1008

Biocane www.biocane.com.br 19 3413-5066 19 3421-2080 19 99773-2125
Centerquimica 18 3631-1313
Microquimica Tradecorp 19 2137-8100
OniBras 16 3969-4957
Sementes Piraí 19 2106-0260
Solenis 11 3089-9225
Stoller 19 3707-1200
UPL do Brasil 19 3794-5600
Painel de comando
Controle
Bambozzi 16 3383-3800
Geraforte 31 3396-9694
Stemac 0800 723 3800

Sucroanalitica www.sucroanalitica.com.br 16 3704-6161
TMSA 51 2131-3333
Verion 11 2100-7400
Willtec 11 4035-7500
Yaskawa 11 3585-1100
Yokogawa 11 3513-1300
Parafusos, porcas, arruelas e buchas - bronze
AllenFix Group 11 3806-2170
Italbronze 11 2436-2900
Açofiltro 15 3225-3005
Brumazi 16 3946-8777
Dedini 19 3403-3222
Equilíbrio 16 3946-2433
Fácil System 16 3014-3270
Fernavan 16 3945-5231

Haver & Boecker www.haverbrasil.com.br 19 2141-2000 19 3879-9100 19 99679-5198
Inbras 11 4056-6644
JW 16 3513-2000
Metalúrgica Rio Grande 16 3173-8100
MVL Máquinas 11 4596-9220
Prominas 16 3375-9119
e triturador
Brumazi 16 3946-8777
Dedini 19 3403-3222
Fácil System 16 3014-3270
Fragmaq 11 4056-8057 Moreno 16 3946-5000
Pinheiro 19 3843-9250
Tecnometal 31 2122-2724
Terex 0800 031 0100
Zanella 41 2111-2300
Picador e triturador
Peças
Açokorte 11 4013-8080
Embremaq 19 3825-1873
Magíster 16 3513-7200
Terex 0800 031 0100
Pintura industrial
Pint Aplicadora 44 3264-4725
0800 343 4021 21 99381-2770
Priner www.priner.com.br
Reframax 31 3029-8002
SGS Brasil 11 3883-8800
Pipa
Fabricação e reforma
Gascom 16 2105-3622
SL Equipamentos 16 3946-3080
Plano de saúde
Hapvida
0800 018 3456
Sermed 16 3945-1212
Plantadora de cana
Agrimec 55 3222-7710
Antoniosi 16 3384-8000
Carderoli 18 3645-1231
Civemasa 16 3382-8282
DMB 16 3946-1800
Duraface 19 3547-3539
Sollus Agrícola 18 3421-1100
TMA 16 3969-4933
Plantio
Monitoramento
AGR 65 3023-0083
Geoambiente 12 3878-6400
Pneumático
Equipamento e acessório
Ascoval 11 4208-1700
Bray Controls 19 3517-6161
Continental ContiTech 0800 011 1572
Cotergavi 11 3673-5020
PW Hidropneumática 19 3801-9500
Tectrol - Dínamo 43 3305-2500
Pneu
Bridgestone Firestone 0800 016 1718
Comercial Rodrigues 11 2093-8004
Continental 11 4583-6161
Goodyear 0800 725 7638
Michelin 21 3621-4711
Pirelli 0800 728 7638
Titan 0800 723-2476
Trelleborg 11 2802-9266
Reforma
GDA Pneus 17 3521-2713
Pneu Forte 16 3202-8604
Tecpolimer 11 3032-6480
Tipler 51 3097-2101
Vipal 54 3242-1666
Pneu Revenda
Copabo 11 3741-6650
Marini 54 3316-4100
Bambozzi 16 3383-3800
Bauma 15 3242-8080
E-Machine 16 3511-9000
GH Pontes Rolantes 11 4409-0066
Mausa 19 3124-3030
Terex 0800 031 0100
Unimaq - Hovam 16 3209-4071
AERO Tecnologia do Ar 11 2152-7100
CBC 11 4431-3900
Clyde Bergemann 19 3811-8080
Delta Ducon 11 3218-6666
HPB www.hpb.com.br 16 3513-4600 Powder 11 3218-6666
Prensa
E-Machine 16 3511-9000
Fragmaq 11 4056-8057
TMSA 51 2131-3333
Prensa desaguadora de lodo
Engenovo 21 2223-0899
Produção de vapor
ComBio 11 3030-0040
Engecass 47 3520-2500
Mitre Engenharia 16 3623-4021
Solid Designer 11 97559-6518
Produto químico
Amonex 11 4789-8989
Aratrop 16 3690-1100 Base Química 16 2101-1200


3943-5283 DuPont 11 4166-8000
Grupo ENG www.grupoeng.ind.br 16 3946-9300
Química www.homyquimica.com.br 16 3690-1000
Produto
Produto químico Alcalinizante
Produto químico
Antibiótico
Buckman 19 3864-5000
Centerquimica 18 3631-1313
Coremal 11 4615-8142
DND Química 16 3943-5283
16 3946-9300
Grupo ENG www.grupoeng.ind.br
OniBras 16 3969-4957
Phibro EPG 0800 722 8011
Química Real 31 3057-2000
Solenis 11 3089-9225
Produto químico
Anticorrosivo
Armo 16 3797-8900
Bardahl 11 4898-8600
Centerquimica 18 3631-1313
16 3946-9300
Grupo ENG www.grupoeng.ind.br
Homy Química www.homyquimica.com.br 16 3690-1000
ITW Chemical 11 4785-2630
Nalco Water 11 5644-6500
Rust Engenharia 11 3140-1500
Produto químico
Antiespumante e anti-incrustante
Alcolina 16 3951-5080
Aratrop 16 3690-1100

Biocane www.biocane.com.br
19 3413-5066 19 3421-2080 19 99773-2125

Buckman
3946-9300
Nalco Water 11 5644-6500
Produto químico
Aratrop

Produto químico
Produto químico

químico
Produto químico

OniBras 16 3969-4957
Solenis 11 3089-9225
Produto químico
Perigoso - Emergência
Suatrans 0800 707 7022
Produto químico
Polímero

Biocane www.biocane.com.br 19 3413-5066 19 3421-2080 19 99773-2125
Buckman 19 3864-5000
Centerquimica 18 3631-1313
DND Química 16 3943-5283
Grupo ENG www.grupoeng.ind.br 16 3946-9300
Lanxess 11 3741-2500
Nalco Water 11 5644-6500
OniBras 16 3969-4957
Skills Quimica 14 3652-5156
Solenis 11 3089-9225
Produto químico
Resina
Armo 16 3797-8900
Coremal 11 4615-8142
Grace 11 4197-7540
Grupo ENG www.grupoeng.ind.br 16 3946-9300
Nalco Water 11 5644-6500
Perfortex 19 3526-1100
Solenis 11 3089-9225
Projeto industrial
AEI Assistech 16 3042-3871
Alkaiós 16 3945-5499
Asperbras 18 3654-7000
Authomathika 16 3513-4000
Azevedo Engenharia 19 3435-3300
Brumazi 16 3946-8777
Catena Engenharia 41 3336-1737
De Smet Empral 16 3209-1999
Engenovo 21 2223-0899
Engevix 11 2106-0100
Engsugar 14 3316-6260
ETEC Engenharia 34 3334-6400
EXAL 19 3411-2171
Fives Lille 16 3947-9029
Icon 48 3431-1800
Intecnial 54 2107-8000
JBR Engenharia 19 3629-0411
Mectrol 14 4009-0507
Metalúrgica Rio Grande 16 3173-8100
NG Metalúrgica 19 3429-7272
Procknor 11 3898-1511
Ram Automação 14 3604-8000
Reunion 11 4156-6688
Solid Designer 11 97559-6518

Sucroanalitica www.sucroanalitica.com.br 16 3704-6161
Proteção contra incêndio
Alvenius 11 4613-6266
Argus Engenharia 19 3826-6670
Bombas Andrade 17 3321-5811
Bozza 11 2179-9966
CF Sistemas 16 3516-3800
Construtec 17 3343-1123
Dafo Brasil 31 3241-2817
Gascom 16 2105-3622
Germek www.germek.com.br 19 3682-7070 19 3682-7071 Mepel 54 3337-3700
Seive 31 3317-6393
SL Equipamentos 16 3946-3080
Working on Fire 19 3246-1534
Proteção contra incêndio
Kit para combate
Argus Engenharia 19 3826-6670
Dafo Brasil 31 3241-2817
Seive 31 3317-6393
SL Equipamentos 16 3946-3080
Proteção contra incêndio
Líquido gerador de espuma
Argus Engenharia 19 3826-6670
Dafo Brasil 31 3241-2817
Miracema-Nuodex 19 3728-1000
Seive 31 3317-6393
SL Equipamentos 16 3946-3080
Proteção contra incêndio
Máquinas e veículos
Argus Engenharia 19 3826-6670
Dafo Brasil 31 3241-2817
Estradeiro 16 3995-9899
Seive 31 3317-6393
Sysmak 17 3011-7414
Proteção contra incêndio
Monitoramento
Argus Engenharia 19 3826-6670
Contech 11 5035-0920
Dafo Brasil 31 3241-2817
Geoambiente 12 3878-6400
Seive 31 3317-6393
Sintecsys 11 3109-1815
Working on Fire 19 3246-1534
Pulverizador
Bozza 11 2179-9966
Feldermann Forest 48 98419-2428
Gascom 16 2105-3622
Herbicat 17 3524-9797
Jacto 0800 772 2100
Martineli Agrícola 16 2105-8000
Matabi 11 5524-1663
Mepel 54 3337-3700
Spraying 11 2124-9500
Pulverizador
Peças e acessórios
Comam 31 3275-2118
Herbicat 17 3524-9797
Matabi 11 5524-1663
Spraying 11 2124-9500
Spraytech 16 3621-5929
Teejet 11 4612-0049
Pulverizador costal
Herbicat 17 3524-9797
Jacto 0800 772 2100
Rastreamento
Autotrac 61 3307-7000
Cotecna 11 3383-1800
Geoambiente 12 3878-6400
Goldensat 0800 580-3030
OnixSat 43 3374-3822
Panorama 12 3204-4686
Tracker 11 3506-5700
Recepção de cana
Sistema, preparo e extração
Azevedo Engenharia 19 3435-3300
Brumazi 16 3946-8777
0800 343 4021 21 99381-2770
Priner www.priner.com.br
Redutor e motorredutor
A.T.I. Brasil 41 3302-3400
Acoplast 31 2566-5900
ADDN 16 3946-3826
Ajel Service 62 3295-3188

19 99203-7859
19 3437-2520
Transtecno
www.interpump.com.br/marcas/ transtecno
Weg-Cestari 16 3244-1000
Zanini Renk 16 3518-9000
Refratário
Menphis 19 3272-4420
Mercosul 16 2105-8987
Reframax 31 3029-8002
Reservatório
Fibra vidro/PRFV
Unifibra 16 3663-8002
Resíduo - gerenciamento

Stolthaven www.stolthaven.com.br 13 3295-9000
Revestimento
Alvenius 11 4613-6266
Armo 16 3797-8900
Chesterton 11 3382-4900
Engcom 19 99645-1329

Haver & Boecker www.haverbrasil.com.br 19 2141-2000 19 3879-9100 19 99679-5198
Henkel 11 3205-8955
Hennings 47 3036-5555
Reframax 31 3029-8002
RLX 16 3101-1414
Rust Engenharia 11 3140-1500
Uniweld 11 4035-8877
Rolamento
A.T.I. Brasil 41 3302-3400
Abrascort 41 2169-9999
Brastrela 11 3868-6100
Cobra 16 3603-3333
Copabo 11 3741-6650
JDF Centrifugas 19 2108-5013
Nachi 11 3284-9844
NSK 11 3269-4700
NTN-SNR 41 3627-8000
Platinum 11 3665-4000
Rolimac 16 3979-7009
Schaeffler 15 3335-1500
SKF 11 4448-8200
Timken 11 5187-9200
Visão 11 2602-6533
Rolamento Recuperação

Intacta www.intactarolamentos.com.br 14 3641-0914 11 98272-0914
Rolo e cilindro
Cofaco 19 3026-8888
Hydac 11 4393-6600
RLX 16 3101-1414
Sulcromo 51 2112-2600
Techmaster 11 4414-1515
Tectrol - Dínamo 43 3305-2500
Rotator
Fácil System 16 3014-3270 PW Hidropneumática 19 3801-9500
Sacaria para açúcar
SR Embalagens 17 3321-2222
Secador
Brumazi 16 3946-8777
E-Machine 16 3511-9000
Fácil System 16 3014-3270
Fives Lille 16 3947-9029
Mausa 19 3124-3030
Metalúrgica Rio Grande 16 3173-8100
Solid Designer 11 97559-6518
Sensor

Secmil www.secmil.com.br 12 3911-9496

Sucroanalitica www.sucroanalitica.com.br 16 3704-6161
Tecnord 19 3412-1890
World Controles 19 3833-3131
Separador de resíduos
Flottweg 19 3836-5300
Servoacionamento
SEW-EURODRIVE
www.sew-eurodrive.com.br 0800 770 0496
Solid Designer 11 97559-6518
Transtecno www.interpump.com.br/marcas/ transtecno 19 99203-7859 19 3437-2520
Silo
Delta Ducon 11 3218-6666
Dujua 47 3534-5000
Engecass 47 3520-2500

Haver & Boecker www.haverbrasil.com.br 19 2141-2000 19 3879-9100 19 99679-5198

Link Steel www.linksteel.com.br
19 3493-9600
Metalúrgica Rio Grande 16 3173-8100
Powder 11 3218-6666
Software
Design, ERP, gestão e processos
AEVO 27 3024-7800
Agile Solutions 11 5501-6555
Comlink 16 2101-4000
Creare Sistemas 51 3094-9090
CS Compusoftware 18 3636-3800
Geoambiente 12 3878-6400
Grupo ERRP 16 3623-0998
Hexagon Agriculture 48 4009-2704
Procenge 81 4009-2877
SAP 0800 888 9988
Sigma Sensors 12 3933-3291
Simova 12 3904-4343
Smar 16 3946-3599
Solinftec
www.solinftec.com 18 3622-2270
Soteica 11 5091-3900
Totvs 0800 709 8100
Veltec 3003-1199
Software
Gestão agrícola
Agile Solutions 11 5501-6555
AGRO TI 16 3603-2720
Auteq 11 2107-1888
CHB Sistemas 16 3713-0200
Creare Sistemas 51 3094-9090
CS Compusoftware 18 3636-3800
Enalta 16 3411-6060
GAtec 19 2106-0888
Hexagon Agriculture 48 4009-2704
TI Agro 11 4225-4091
Solda Equipamentos e Consumíveis
Aluga Solda 11 4617-9696
Bambozzi 16 3383-3800
Comaso 16 3513-5230
Magíster 16 3513-7200
Martineli Agrícola 16 2105-8000
Nicrosol 11 5523-0522
Serflex 16 2105-0404
Uniweld 11 4035-8877
Voestalpine Böhler Welding 11 5694-8377
E-Machine 16 3511-9000
IRBI 18 3631-5000
Motocana 19 3412-1234
Clyde Bergemann 19 3811-8080
Herom 16 2105-7200
Promoen 16 3513-2900
Sulfitação
Equipamento
Brumazi 16 3946-8777
Engenovo 21 2223-0899
Simisa 16 2105-1200
Supressor de poeira

Tanque
Águia Inox 54 3464-0191
Brumazi 16 3946-8777
Dedini 19 3403-3222
Fimaco 47 3525-1000
LDA Tanques 19 3838-9595

Link Steel www.linksteel.com.br
19 3493-9600
Mega Flux Bombas 11 5575-4160
Metalúrgica Rio Grande 16 3173-8100
Sage Oil Vac Brasil 11 2631-6343
Stringal 11 4347-9088
Unifibra 16 3663-8002
Tanque de água
Impacto Implementos 14 3623-9444
SL Equipamentos 16 3946-3080
Tela
Açofiltro 15 3225-3005
Big Telas 19 3469-4411
Elof Hansson 11 3101-5257
Equilíbrio 16 3946-2433
Expametal 16 3797-5100

Haver & Boecker www.haverbrasil.com.br 19 2141-2000 19 3879-9100 19 99679-5198
Intertelas 19 3421-8975
Okubo 16 3514-9966
Permetal 11 2823-9200
Prominas 16 3375-9119
Solpack 19 3493-9900
Termocompressor
Solid Designer 11 97559-6518
Torre de destilação
Peças e serviços
Clark Solutions 11 3472-3333
E-Machine 16 3511-9000
JW 16 3513-2000
Metalúrgica Rio Grande 16 3173-8100
TKS 16 3942-2022
Torre de Resfriamento de água
Alfaterm www.alfaterm.com.br 11 4156-8930
Alpina 11 4397-9133
CQI 16 3324-2874
Delta Ducon 11 3218-6666
E-Machine 16 3511-9000
Powder 11 3218-6666
Tecniplas 11 4528-0090
Vettor 11 4409-0310
Transbordo
Antoniosi 16 3384-8000
Civemasa 16 3382-8282
E-Machine 16 3511-9000
Motocana 19 3412-1234
Teston 44 3351-3500
TMA 16 3969-4933
Usingá 44 3266-2125
Transformador
ABB 0800 014 9111
Adelco 11 4199-7500
Ajel Service 62 3295-3188
Romagnole 44 3233-8500
Soltran 11 2813-6222
Transmissor de vazão
Hydac 11 4393-6600
Smar 16 3946-3599
Transportador
Brumazi 16 3946-8777
Fácil System 16 3014-3270
Fourteam Engenheiros 22 2733-1441

Haver & Boecker www.haverbrasil.com.br 19 2141-2000 19 3879-9100 19 99679-5198

Link Steel www.linksteel.com.br
19 3444-7763
19 3493-9600
Metalúrgica Rio Grande 16 3173-8100
Moreno 16 3946-5000
Solid Designer 11 97559-6518
Techmaster 11 4414-1515
Tecnometal 31 2122-2724
TMSA 51 2131-3333
Transportador Componentes
Brumazi 16 3946-8777
General Chains 19 3417-2800
Imepel 48 3433-4211

Link Steel www.linksteel.com.br 19 3493-9600
Prolink 19 3423-4000
51 2131-3333
Transportador de Caneca, correia e correntes
Dujua 47 3534-5000
E.M.G. 41 3641-7200

Haver & Boecker www.haverbrasil.com.br

Link Steel www.linksteel.com.br
19 2141-2000 19 3879-9100 19 99679-5198
19 3493-9600
Martin Sprocket 19 3877-9400
TMSA 51 2131-3333
Zanella 41 2111-2300
Transportador Pneumático
AERO Tecnologia do Ar 11 2152-7100
Astral Ambiental 41 3346-2200
Bernauer 11 2666-3909
Delta Ducon 11 3218-6666
Dynamic Air 11 4597-8000

Haver & Boecker www.haverbrasil.com.br
19 2141-2000 19 3879-9100 19 99679-5198
Powder 11 3218-6666
Transporte de biometano
19 3682-7070 19 3682-7071
Germek www.germek.com.br
Tratamento Água e efluentes - Equipamentos
Acquasys 11 3628-1982
Atag Water 11 4070-5220
B&F Dias 19 3886-9600

BMA Ambiental www.bmaambiental.com.br 31 3649-1450 31 99781-6390
Engcom 19 99645-1329
Engenovo 21 2223-0899
EP Engenharia 11 2463-7700
Filtrando 11 2595-1300
Fluid Brasil 11 3378-7500
Grundfos 11 4393-5533
Krieger 47 3231-1311
Metalúrgica Rio Grande 16 3173-8100
Paques 19 3429-0600
Perenne 11 3022-6989
ProMinent 11 4176-0722

Sucroanalitica www.sucroanalitica.com.br 16 3704-6161
Suez Brasil 11 2166-3600
Tera 11 3963-6500
Unifibra 16 3663-8002
Vibropac 11 2108-5600
Wasserlink 11 5581-0076
Tratamento Água e efluentes - Produtos
Acquaquímica 51 3205-2233
Alcolina 16 3951-5080
Atag Water 11 4070-5220
Base Química 16 2101-1200

Biocane www.biocane.com.br 19 3413-5066 19 3421-2080 19 99773-2125
BTA Aditivos 49 2020-0020 Buckman 19 3864-5000
Centerquimica 18 3631-1313
Compass Minerals 11 3016-9600
Coremal 11 4615-8142
Degani-Vaduz 11 2085-7777
DND Química 16 3943-5283
Dryller 31 3286-8004
Filtrando 11 2595-1300
Grupo ENG www.grupoeng.ind.br 16 3946-9300
Kemira 11 2189-4900
KSB 11 4596-8500
Kurita 19 3827-8388
Miika Nacional 31 3151-7861
Miracema-Nuodex 19 3728-1000
Nalco Water 11 5644-6500
SGS Brasil 11 3883-8800 Sigma Sensors 12 3933-3291
OniBras 16 3969-4957
Sabará 19 3455-8900
Serquímica 16 2105-8222

Sucroanalitica www.sucroanalitica.com.br
16 3704-6161
Suez Brasil 11 2166-3600
Veolia 11 3888-8800
SD Engenharia 16 3524-4801
Thermix 19 3881-5040
Budny 48 3432-0096
E-Machine 16 3511-9000
John Deere 0800 891 4031
LS Mtron 47 3085-8101
Mahindra 11 3060-5700
Terraverde 19 3674-0000
Tracan 16 3456-5400
Tracbel 0800 200 1000
Tracbel Agro www.tracbelagro.com.br/ 16 3968-8080
Valtra 11 4795-2000
XCMG 0800 770 8866
Peças e serviços
AGS 16 3952-1683
ITR 11 3340-7555
John Deere 0800 891 4031
Lopes Tratores 16 3628-6622
Marini 54 3316-4100
Panegossi 16 3383-2000
Terraverde 19 3674-0000
Tracan 16 3456-5400
Tracbel Agro www.tracbelagro.com.br/ 16 3968-8080
Tratorag 19 3429-1444
Trocador de calor
Agapito 16 3946-2130
Alfa Laval 11 5188-6000
Ártica 19 3878-4800
Bermo 47 2123-4444
Caldema 16 3946-2701 CBC 11 4431-3900
Delta Ducon 11 3218-6666
E-Machine 16 3511-9000
Evacon 11 4059-0059
Fourteam Engenheiros 22 2733-1441
FW 16 3041-6600
GEA Westfalia 19 3725-3100
Hydac 11 4393-6600
ICP Latin América 11 4496-4320
JDF Centrifugas 19 2108-5013
Metalúrgica Rio Grande 16 3173-8100
Powder 11 3218-6666
Tetralon 11 4081-7000
Torfer 11 5058-6118
Tranter 11 4617-6550
Tubal 11 4606-8800
Aços Motta 11 3385-8778
Açotubo 11 2413-2000
Alvenius 11 4613-6266
Aperam 11 3818-1700
Atlas Copco 11 3478-8883
Bermo 47 2123-4444
Carbinox 11 4795-9000
Centerval 19 2105-1200
Comam 31 3275-2118
Comega 16 3969-9660
Contuflex 11 3070-0300
D&D Company 11 4072-4222
Edra 19 3576-9300
Elinox 11 2065-1400
Engcom 19 99645-1329
Fluxo Control 11 2436-3888
Franpar 16 2133-4383
InoxPira 19 3432-9838
Intersteel 11 2067-3536
Irrigabrás 11 2842-6464
Jatinox 11 2060-0405
JEA 11 4547-6000

Joplas www.joplas.com.br 19 3186-9960 19 99292-8394
Neolíder 11 4393-6000
Omega Tubos 16 2138-4500
Petrofisa 41 3626-8800
Senior 11 4136-4514
SR Tubos 16 3946-4770
SSAB 11 3303-0800
Stringal 11 4347-9088
Suprir 16 2102-6500
TCA 11 2065-6565
Tecniplas 11 4528-0090
Termomecanica www.termomecanica.com.br 11 4366-9799 11 4366-9777
Tubos Ipiranga 11 4391-6000
Tubos Oliveira 11 3186-8000
Tubos Verola 16 3456-0404
Tuper 47 3631-5000
Vetro www.vetro.com.br 16 99962-5625
E-Machine 16 3511-9000
Engecass 47 3520-2500
Interunion 16 2102-9200
82 2121-2000
16 2105-2600 Turbimaq 19 3437-5700 Zanini Turbinas 16 98228-2403
Turbina Manutenção Siemens 0800 119 484 TGM 16 2105-2600 Turbimaq 19 3437-5700 Zanini Turbinas 16 98228-2403
Peças de reposição
Siemens 0800 119 484
Turbina
Projetos
Siemens 0800 119 484
TGM 16 2105-2600
Turbimaq 19 3437-5700
Zanini Turbinas 16 98228-2403
Turbocompressor
Cummins 0800 286 6467 MWM 11 3882-3200
Solid Designer 11 97559-6518 Volvo 41 3317-8111
ABB 0800 014 9111 Texas 82 2121-2000
Usinagem e Retífica de precisão
Açokorte 11 4013-8080
Estradeiro 16 3995-9899
Fundição Água Vermelha 16 3513-2300
NG Metalúrgica 19 3429-7272 Siemens 0800 119 484
FW 16 3041-6600
TransmiService 16 3946-4600
Usina da Peça 16 3384-2121
Vemag 16 3511-1000
Zanini Renk 16 3518-9000
Zanini Serviços 16 3518-9090
ZBN 18 2102-9000
Aços Motta 11 3385-8778
ACT 11 2893-9670
AERO Tecnologia do Ar 11 2152-7100
Alfa Laval 11 5188-6000
Alvenius 11 4613-6266
Argus Engenharia 19 3826-6670
Ascoval 11 4208-1700
Bray Controls 19 3517-6161
Circor 19 3124-3124
Contech 11 5035-0920
Danfoss 11 2135-5400
E-Machine 16 3511-9000
Engeval 19 3543-8854
EXAL 19 3411-2171
Fácil System 16 3014-3270
Ferroleto 16 3969-9200
Fluxo Control 11 2436-3888
Foxwall 11 3454-0200
Herbicat 17 3524-9797
Herom 16 2105-7200
Hidro-Ambiental 19 3572-9999
Hydac 11 4393-6600
IMI Interativa 15 3235-9500
Interválvulas 16 3516-7200
KSB 11 4596-8500
LESER 21 3195-5350
Magnus Hidráulica 11 2422-7944
Moreno 16 3946-5000
Neles 15 2102-9600
Neolíder 11 4393-6000
Nicsa 11 5525-4122
Parker 12 4009-3500
Planusi 16 3513-9900
Promoen 16 3513-2900
RTS Válvulas 11 2423-7322
SGS Brasil 11 3883-8800
SMV 19 2105-1266
Stauff 11 4772-7200
Suprir 16 2102-6500
Tecnord 19 3412-1890
Tecnoval 16 3944-9900
Tectrol - Dínamo 43 3305-2500
TJA 16 3953-9696
TMSA 51 2131-3333
Unival 11 2858-9000
Valeq 21 3101-1224
Vallair 11 2696-3411
Valmec 11 3186-5700
Valvugás 11 3604-8833
Verion 11 2100-7400
W.Burger 11 5525-4355
WM Válvulas 11 2116-3335
Zanardo 18 3117-1195
Andritz 41 2103-7601
Caldema 16 3946-2701
CBC 11 4431-3900
Evacon 11 4059-0059
Fives Lille 16 3947-9029
JRE Inspeções e Ensaios 19 3454-1292
Metalúrgica Rio Grande 16 3173-8100
SGS Brasil 11 3883-8800
Solid Designer 11 97559-6518
A.T.I. Brasil 41 3302-3400
CBV 11 4418-8080
Chesterton 11 3382-4900
Cobra 16 3603-3333
Ferroleto 16 3969-9200
Freudenberg 11 4072-8000
Hennings 47 3036-5555
Hidrara

www.hidrara.com.br 16 3508-1300
Luciane 11 4414-1700
Parker 12 4009-3500
Parkits 19 3421-8485
Real 19 3444-6737
Sotequi 11 3831-9858
Unimil 19 2105-0800
AERO Tecnologia do Ar 11 2152-7100
Airblower Ventiladores 11 99406-6066
Astral Ambiental 41 3346-2200
Bernauer 11 2666-3909
Delta Ducon 11 3218-6666
E-Machine 16 3511-9000
Equilíbrio 16 3946-2433
Euroair 54 3227-2753
Krieger 47 3231-1311
Powder 11 3218-6666
Roster 54 3332-1313
Stringal 11 4347-9088
Tecnovento 11 4497-0671
Ventec 19 3801-8800
Vergalhão

JW 16 3513-2000
Valmet 41 3341-4444
1. Para a empresa produtora: Ano que vem, divulgue no Anuário de Sustentabilidade da Revista Opiniões do sistema bioenergético e/ou florestal, as suas ações sociais e ambientais realizadas para seus funcionários e nas cidades do entorno das Unidades. Só fique de fora se sua empresa não fez absolutamente nada nestas áreas.
2. Para a empresa fornecedora: Ano que vem, exponha a marca e os produtos da sua empresa no Guia de Compras da Revista Opiniões do sistema florestal e/ou bioenergético – parte integrante do Anuário de Sustentabilidade destes dois Sistema. Você pode inserir links diretos com suas mídias sociais, com o seu Site, e, até vídeos, dentre outras opções.


Lembre-se: quem é visto é lembrado!








fornecedora
O Anuário de Sustentabilidade do sistema Sucroenergético tem o objetivo de registrar as centenas de ações ambientais e sociais, anualmente realizadas pelas empresas produtora de etanol, açúcar, bioeletricidade, biogás, biometano, biohidrogênio, por todo o Brasil.
O Guia de Compras é a vitrine ideal para apresentar a marca, os produtos e os serviços da sua empresa para este público.
• Fechamento: 23 Set 2026
If your company is a producer or supplier of bioenergy systems, highlight your trademark. The Sugarcane Energy System Sustainability Yearbook, of Opiniões Magazine, aims to record the hundreds of environmental and social actions carried out annually by companies producing ethanol, sugar, bioelectricity, biogas, biomethane, and biohydrogen throughout Brazil.
The Buyer's Guide is the ideal showcase to present your company's trademark, products, and services to this audience.
• Deadline: 2026, September 23
2025 anuário de sustentabilidade
do sistema florestal brasileiro & 2026














Se sua empresa é produtora ou fornecedora do sistema florestal, mostre sua marca.
O Anuário de Sustentabilidade da Revista Opiniões tem o objetivo de registrar as centenas de ações sociais e ambientais, anualmente realizadas pelas empresas de base florestal por todo o Brasil, em favor de seus empregados e de toda a população das cidades que vivem no seu entorno.
O Guia de Compras é a vitrine ideal para apresentar a marca, os produtos e os serviços da sua empresa para este público.
• Fechamento: 24 Jun 2026
If your company produces or supplies products for the forestry system, highlight your trademark. The Forest System Sustainability Yearbook from Opiniões Magazine aims to record the hundreds of social and environmental actions carried out annually by companies in the forestry sector throughout Brazil, benefiting their employees and the entire population of neighboring cities.
The Buyer's Guide is the ideal showcase to present your company's trademark, products, and services to this audience.
• Deadline: 2026, June 24
Opiniões Opiniões Opiniões
do sistema florestal brasileiro & 2026

2025 anuário de sustentabilidade







Opiniões Opiniões Opiniões


2025 anuário de sustentabilidade Guia de Compras das empresas de
Free access to all editions from our 23 years of operation
São 3.788 artigos, sobre 189 diferentes temas, escritos com exclusividade pelas maiores autoridades dos assuntos no país. Você tem 2 formas para ler as revistas:
1. Pela edição Digital, folheando as páginas como em uma antiga revista. Nesta opção você pode fazer o download da edição inteira, para ler quando estiver off-line, ou
2. Por texto corrido, lendo os artigos individualmente com livre acesso aos textos e imagens, nos 7 idiomas disponíveis.
There are 3,788 articles, covering 189 different topics, written exclusively by the leading authorities on these subjects in the country.
You have two ways to read the magazines:
1. Through the Digital edition (in Portuguese), flipping through the pages like an old magazine. In this option, you can download the entire edition to read offline, or
2. By reading the articles individually with free access to the texts and images, in the 7 available languages.







Opiniões Magazine: The world magazine of Brazilian agribusiness.

operation on our website.
Sucroenergética Biblioteca Florestal

Acesso ao Site


Áreas de interesse
Areas of interest
Edição Bioenergética
Bioenergy Edition
• Cana
• Milho
• Agave
• Macaúba
• Açúcar
• Etanol
• Biodiesel
• Biogás
• Biometano
• Bioeletricidade
• Mercado de Carbono
• Ração animal
Edição Florestal
Forestry Edition
• Celulose
• Papel
• Carvão
• Siderúrgia
• Painéis
• Madeira
• Produtos não-madeireiros
Cadastre-se para passar a receber as Revistas Opiniões, em qualquer parte do mundo, de forma regular e gratuita. Somos uma revista indexada, com 23 anos de atividade. Envie um email para Jornalismo@revistaopinioes.com.br
According to Google Analytics records, the large blue area shows the location of readers of Opiniões Magazine after we started publishing it in 7 languages. 4 billion people on Planet Earth speak one of the languages in which Opiniões magazine is written. Sign up to receive Opiniões Magazine regularly and free of charge, anywhere in the world. We are an indexed magazine with 23 years of activity. Send an email to Jornalismo@revistaopinioes.com.br


Marketing :+55 16 99773-2200
Jornalismo:+55 16 99777-7799
Jornalismo@RevistaOpinioes.com.br www.RevistaOpinioes.com.br
Imagine se você descobrisse que o médico com o qual você vai fazer uma cirurgia cardíaca na manhã seguinte se formou há 20 anos como o melhor aluno da sua classe, na melhor faculdade de medicina do País. Muito bom, não?
Entretanto, nos últimos 20 anos, ele não leu nenhum livro, nem participou de nenhum congresso, nem teve por costume ler regularmente revistas especializadas da sua área médica. Você faria a cirurgia em paz?

No que se refere a nossa área, quantas tecnologias foram desenvolvidas e implantadas nessas duas décadas como o estado da arte e, depois de algum tempo, substituídas por uma nova opção, muito mais eficaz e eficiente, que tomaria o lugar da anterior, até ser igualmente substituída por uma mais nova ainda.
Quantas pragas e doenças apareceram, desapareceram, e algumas até voltaram? Quantas técnicas foram substituídas nesses últimos 20 anos?
Nenhum conhecimento é definitivamente eterno. A faculdade está sempre atualizada, mas tão somente até o dia da sua formatura. Os livros, igualmente, até o dia da sua publicação. As opções que são continuadamente atualizadas são os congressos e as publicações regulares das áreas.
Conhecendo esse cenário e o que passou a representar nesses 23 anos de operação para as universidades, centros de pesquisa e empresas do sistema agrícola e florestal, a Revista Opiniões decidiu abrir inscrições gratuitas para que todos os estudantes, professores e cientistas de todos os cursos de agroconhecimento de qualquer parte do mundo, passem a receber todas as nossas publicações.
Todos os artigos da Revista Opiniões têm textos publicados em 7 idiomas, quais sejam: português, espanhol, inglês, francês, chinês, árabe e hindi, cobrindo a língua falada pelo incrível numero de mais de 4 Bilhões de pessoas.
O objetivo é fazer com que o estudante, desde o primeiro dia de aula, passe a participar da vida empresarial na qual se integrará, em alguns anos, já com atualizado conhecimento do que está sendo discutido, avaliado e implantado nas empresas.
Muitos dos executivos e cientistas que hoje escrevem na Revista Opiniões declararam que liam nossas edições desde quando ainda eram estudantes nas universidades.
Ampliando o projeto de Educação Continuada, decidimos também abrir as inscrições gratuitas para todos os funcionários das áreas técnicas, agrícolas, industriais e administrativas das empresas produtoras e fornecedoras dos sistemas florestal e bioenergético de qualquer parte do Brasil e do mundo.
O acesso à informação dirigida é a mais eficiente forma de unificar e atualizar o conhecimento entre todos os funcionários em cargos de comando, bem como preparar os funcionários em ascensão para assumir estes cargos. Esta é a mais natural forma de gerar a Educação Continuada.
Para passar a receber regular e gratuitamente as edições de nossas revistas, basta enviar um e-mail com os dados abaixo:
• Para: Jornalismo@RevistaOpinioes.com.br
• Assunto: Educação Continuada Gratuita
• Informe apenas:
- O seu Nome
- e-mail profissional
- e-mail pessoal
William Domingues de Souza Editor-chefe das Revistas Opiniões
WDS@RevistaOpinioes.com.br Celular e WhatsApp: +55 16 99777-7799
Imagine if you found out that the doctor you're going to have heart surgery with the next morning graduated 20 years ago as the top student in his class at the best medical school in the country. Pretty good, right?
However, in the last 20 years, he hasn't read any books, attended any conferences, or regularly read specialized magazines in his medical field. Would you have the surgery done in peace?

In our field, how many technologies have been developed and implemented in these two decades as state-of-the-art, only to be replaced after some time by a new, much more effective and efficient option, which would take the place of the previous one, until it too was replaced by an even newer one?
How many pests and diseases have appeared, disappeared, and some have even returned? How many techniques have been replaced in the last 20 years?
No knowledge is truly eternal. University is always up-to-date, but only until the day you graduate. Books, likewise, are up-to-date until the day they are published. The options that are continuously updated are conferences and regular publications in the fields.
Knowing this scenario and what it has come to represent in these 23 years of operation for universities, research centers, and companies in the agricultural and forestry sectors, Opinions Magazine decided to open free registration so that all students, professors, and scientists from all agricultural knowledge courses from anywhere in the world can receive all of our publications.
All articles in Opinions Magazine are published in 7 languages: Portuguese, Spanish, English, French, Chinese, Arabic, and Hindi, covering the languages spoken by an incredible number of over 4 billion people.
The goal is for the student, from the very first day of class, to participate in the business world into which they will integrate in a few years, already possessing up-to-date knowledge of what is being discussed, evaluated, and implemented in companies.
Many of the executives and scientists who write for Opinions Magazine today have stated that they have been reading our editions since they were still students at universities.
Expanding the Continuing Education project, we have also decided to open free registration to all employees in the technical, agricultural, industrial, and administrative areas of companies that produce and supply forestry and bioenergy systems from anywhere in Brazil and the world.
Access to targeted information is the most efficient way to unify and update knowledge among all employees in management positions, as well as to prepare employees on the rise to assume these positions. This is the most natural way to generate Continuing Education.
To start receiving regular, free issues of our magazines, simply send an email with the information below:
• To: Jornalismo@RevistaOpinioes.com.br
• Subject: Free Continuing Education
• Please provide only:
- Your name
- Professional email address
- Personal email address
William Domingues de Souza Editor-in-Chief of Opiniões Magazines
WDS@RevistaOpinioes.com.br
WhatsApp (only): +55 16 99777-7799


Editora WDS Ltda e Editora VRDS Brasil Ltda: Rua Jerônimo Panazollo, 350 - 14096-430, Ribeirão Preto, SP, Brasil - Pabx: +55 16 3965-4606 - e-Mail Geral: Opinioes@ RevistaOpinioes.com.br •Diretor Geral de Operações e Editor-chefe: William Domingues de Souza - WDS@ RevistaOpinioes.com.br - Whats App: +55 16 99777-7799
•Coordenadora de Marketing: Valdirene Ribeiro Souza - Fone: 16 3965-4606 - VRDS@RevistaOpinioes.com.br
•Vendas Operacionais: • Priscila Boniceli de Souza Rolo - Fone: 16 99132-9231 - pboniceli@gmail.com •Jornalista Responsável: William Domingues de Souza - MTb35088jornalismo@RevistaOpinioes.com.br
•Projetos Futuros: Julia Boniceli Rolo -16 2604-2006 - JuliaBR@RevistaOpinioes.com.br • Projetos Avançados: Luisa Boniceli Rolo -16 2304-2012 - LuisaBR@RevistaOpinioes.com.br •Correspondente na Europa (Augsburg Alemanha): Sonia Liepold-Mai - Fone: +49 821 48-7507 - sl-mai@T-online. de •Copydesk: Katja Augusto - katja.augusto@gmail.com - +351 91385-6862 - Portugal - UE •Edição Fotográfica: Priscila Boniceli de Souza Rolo - Fone: 16 99132-9231 - pboniceli@gmail.com •Artigos: Os artigos refletem individualmente as opiniões pessoais sob a responsabilidade de seus próprios autores •Foto da Capa: Acervo Opiniões •Participantes: Acervo Zilor •Abertura da publicação: Acervo Zilor •Foto da Abertura do Anuário: Acervo Opiniões •Foto da Abertura do Guia de Compras: Acervo Zilor •Foto de todos os Anuários: Acervo Opiniões •Foto da página do Índice: Montagem Opiniões •Fotos dos Articulistas: Acervo Pessoal dos Articulistas e de seus fotógrafos pessoais ou corporativos •Ilustração dos Artigos: As fotos, vídeos, gráficos e demais ilustrações de cada artigo são fornecidas pelos Articulistas e/ou pela sua Assessoria de Comunicação, sendo, portanto, de suas responsabilidades o cuidado com os direitos autorais dos mesmos. •Foto da Próxima sucroenergética: acervo Revista Opiniões •Foto da Próxima edição Florestal: acervo Revista Opiniões •Foto do Expediente: Acervo Zilor •Fotos de Ilustrações: Paulo Alfafin Fotografia - 19 3422-2502 - 19 98111-8887- paulo@pauloaltafin. com.br • Ary Diesendruck Photografer - 11 3814-464411 99604-5244 - ad@arydiesendruck.com.br • Tadeu Fessel Fotografias - 11 3262-2360 - 11 95606-9777tadeu.fessel@gmail.com • Mailson Pignata - mailson@ aresproducoes.com.br - fone: 16 99213-2105 • Acervo Revista Opiniões e dos específicos articulistas •Expedição Revista Digital: 35.713 •Revista Digital: Cadastre-se no Site da Revista Opiniões através do serviço de Fale Conosco e receba as edições diretamente em seu computador ou celular •Portal: Estão disponíveis em nosso Site todos os artigos, de todos os articulistas, de todas as edições, de todas as divisões das publicações da Editora WDS, desde os seus respectivos lançamentos, com livre possibilidade para donwload •Auditoria de Veiculação e de Sistemas de controle: Liberada aos anunciantes a qualquer hora ou dia, sem prévio aviso, através de visita virtual • Home-Page: www.RevistaOpinioes.com.br
ISSN - International Standard Serial Number: 2177-6504
Conselho Editorial da Revista Opiniões:
Divisão Florestal: • Amantino Ramos de Freitas • Antonio Paulo Mendes Galvão • Augusto Praxedes Neto • Caio Eduardo Zanardo • Celso Edmundo Bochetti Foelkel • Eduardo Mello • Edimar de Melo Cardoso • Fernando Campos Passos • João Fernando Borges • Joésio Deoclécio Pierin Siqueira • José Ricardo Paraiso Ferraz • Luiz Ernesto George Barrichelo • Maria José Brito Zakia • Mario Sant'Anna Junior • Mauro Quirino • Mauro Valdir Schumacher • Moacyr Fantini • Moacir José Sales Medrado • Nelson Barboza Leite • Roosevelt de Paula Almado • Sebastião Renato Valverde • Walter de Paula Lima
Divisão Sucroenergética: • Eduardo Pereira de Carvalho
• Evaristo Eduardo de Miranda • Jaime Finguerut • Jairo Menesis Balbo • José Geraldo Eugênio de França • Julio Maria M. Borges • Luiz Carlos Corrêa Carvalho, Caio • Manoel Vicente Fernandes Bertone • Marcos Guimarães Andrade Landell • Marcos Silveira Bernardes • Martinho Seiiti Ono • Nilson Zaramella Boeta • Paulo Adalberto Zanetti • Pedro Robério de Melo Nogueira • Plinio Mário Nastari • Raffaella Rossetto • Tadeu Luiz Colucci de Andrade
plataforma digital multimídia da Revista Opiniões